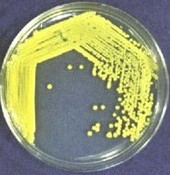
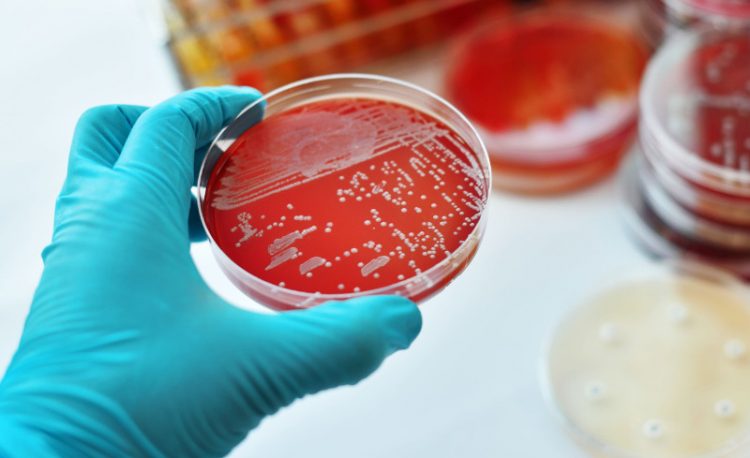

Раздел предназначен для новых сотрудников. Здесь вы узнаете историю компании СИТИЛАБ, познакомитесь с корпоративными правилами, требованиями по охране труда и основами информационной безопасности.

Раздел предназначен для новых сотрудников. Здесь вы узнаете историю компании СИТИЛАБ, познакомитесь с корпоративными правилами, требованиями по охране труда и основами информационной безопасности.

Базовый курс обучения медицинских сестёр компании СИТИЛАБ содержит материалы по основным направлениям деятельности: стандарты работы, клинические процессы, взаимодействие с пациентами и корпоративные требования. Курс помогает новичкам уверенно начать работу и соблюдать единый уровень качества.

Базовый курс обучения администраторов компании СИТИЛАБ включает материалы по ключевым направлениям: взаимодействие с пациентами, работа с документацией, соблюдение стандартов сервиса, информирование о услугах и корпоративные требования. Программа помогает новичкам уверенно начать работу и поддерживать единый уровень качества

Академия СИТИЛАБ — это центр обучения, где собраны материалы по ключевым направлениям работы. Здесь вы найдёте информацию, которая поможет развиваться и повышать профессиональные навыки.

Курс "Школа Старшей медицинской сестры" предназначен для повышения профессиональных навыков старших медицинских сестер.
В рамках обучения участники освоят управление командой, стандарты работы, работу с кадровым учетом, контроль качества и санитарных требований, а также вопросы безопасности и взаимодействия с внешними контролирующими организациями. Курс помогает развить лидерские качества, навыки организации и обеспечения высокого уровня медицинского обслуживания.

Изучите базовой курс обучения для менеджеров и начните свой путь к успешной карьере в управлении. Этот курс предназначен для тех, кто хочет освоить основные навыки работы в управлении, погрузиться в бизнес-процессы и узнать больше о компании Ситилаб.
Что вы узнаете:
Что является продуктом Ситилаб: Узнаете, какие есть анализы в компании Ситилаб, наши эксклюзивы и конкурентные преимущества.
Знакомство с бизнес-процессами: Познакомьтесь с ключевыми бизнес-процессами компании, разберитесь в их взаимодействии и влиянии на общий успех.
Работа в программе Ситилаб: Получите знания о IT продуктах в программе Ситилаб, сможете эффективно подбирать инструменты для работы.
Присоединяйтесь к нам, чтобы начать ваш путь к успеху в управлении!

Изучите базовой курс обучения для менеджеров и начните свой путь к успешной карьере в управлении. Этот курс предназначен для тех, кто хочет освоить основные навыки работы в управлении, погрузиться в бизнес-процессы и узнать больше о компании Ситилаб.
Что вы узнаете:
Что является продуктом Ситилаб: Узнаете, какие есть анализы в компании Ситилаб, наши эксклюзивы и конкурентные преимущества.
Знакомство с бизнес-процессами: Познакомьтесь с ключевыми бизнес-процессами компании, разберитесь в их взаимодействии и влиянии на общий успех.
Работа в программе Ситилаб: Получите знания о IT продуктах в программе Ситилаб, сможете эффективно подбирать инструменты для работы.
Понимание экономических показателей: Ознакомьтесь с основными экономическими показателями компании, поймите их важность и как вы можете на них влиять.
Кому предназначен курс:
Этот курс идеально подходит для начинающих менеджеров и специалистов, которые стремятся углубить свои знания в управлении и подготовиться к эффективной работе в динамичной корпоративной среде.
Присоединяйтесь к нам, чтобы начать ваш путь к успеху в управлении!

Изучите базовой курс обучения для менеджеров и начните свой путь к успешной карьере в управлении. Этот курс предназначен для тех, кто хочет освоить основные навыки работы в управлении, погрузиться в бизнес-процессы и узнать больше о компании Ситилаб.
Что вы узнаете:
Что является продуктом Ситилаб: Узнаете, какие есть анализы в компании Ситилаб, наши эксклюзивы и конкурентные преимущества.
Знакомство с бизнес-процессами: Познакомьтесь с ключевыми бизнес-процессами компании, разберитесь в их взаимодействии и влиянии на общий успех.
Работа в программе Ситилаб: Получите знания о IT продуктах в программе Ситилаб, сможете эффективно подбирать инструменты для работы.
Присоединяйтесь к нам, чтобы начать ваш путь к успеху в управлении!

Изучите базовой курс обучения для менеджеров и начните свой путь к успешной карьере в управлении. Этот курс предназначен для тех, кто хочет освоить основные навыки работы в управлении, погрузиться в бизнес-процессы и узнать больше о компании Ситилаб.
Что вы узнаете:
Что является продуктом Ситилаб: Узнаете, какие есть анализы в компании Ситилаб, наши эксклюзивы и конкурентные преимущества.
Знакомство с бизнес-процессами: Познакомьтесь с ключевыми бизнес-процессами компании, разберитесь в их взаимодействии и влиянии на общий успех.
Работа в программе Ситилаб: Получите знания о IT продуктах в программе Ситилаб, сможете эффективно подбирать инструменты для работы.
Понимание экономических показателей: Ознакомьтесь с основными экономическими показателями компании, поймите их важность и как вы можете на них влиять.
Кому предназначен курс:
Этот курс идеально подходит для начинающих менеджеров и специалистов, которые стремятся углубить свои знания в управлении и подготовиться к эффективной работе в динамичной корпоративной среде.
Присоединяйтесь к нам, чтобы начать ваш путь к успеху в управлении!

Изучите базовой курс обучения для менеджеров и начните свой путь к успешной карьере в управлении. Этот курс предназначен для тех, кто хочет освоить основные навыки работы в управлении, погрузиться в бизнес-процессы и узнать больше о компании Ситилаб.
Что вы узнаете:
Что является продуктом Ситилаб: Узнаете, какие есть анализы в компании Ситилаб, наши эксклюзивы и конкурентные преимущества.
Знакомство с бизнес-процессами: Познакомьтесь с ключевыми бизнес-процессами компании, разберитесь в их взаимодействии и влиянии на общий успех.
Присоединяйтесь к нам, чтобы начать ваш путь к успеху в управлении!

Изучите базовый курс для руководителей розницы и начните путь к карьере в управлении. Этот курс создан для тех, кто хочет освоить ключевые управленческие навыки, понять основы бизнес-процессов и познакомиться с корпоративной структурой и стандартами компании СИТИЛАБ.

Тест содержит 70 вопросов. Ограничение по времени-2,5 часа. Каждый вопрос содержит один правильный ответ.

Здесь Вы найдете всё,
что нужно знать по актуальной методике проектного управления в ГК СИТИЛАБ
Актуальность программы обусловлена необходимостью освоения современных
методов решения профессиональных задач, требующих от врача-специалиста знаний
новейших диагностических и терапевтических методик.
Лабораторные исследования являются необходимым и первейшим мероприятием в
постановке точного диагноза и последующем назначении адекватного и правильного
лечения. По данным ВОЗ, при помощи лабораторных анализов специалист получает
примерно до 80% точной информации о состоянии здоровья пациента. Особенно важное
значение имеют профилактическая диагностика. При помощи анализов проведённых в
лаборатории, можно обнаружить начальные стадии болезни, когда самих симптомов ещё нет.
Профилактические лабораторные исследования — это залог ранней своевременной
диагностики и адекватной терапии. Лабораторные исследования занимают особое место в
диагностике хронических заболеваний и инфекций.

Актуальность программы обусловлена необходимостью освоения современных методов решения профессиональных задач, требующих от врача-специалиста знаний новейших диагностических и терапевтических методик.
В Российской Федерации наблюдается устойчивое снижение заболеваемости туберкулезом и смертности от него. Однако, несмотря на достигнутые результаты, эпидемическая ситуация по туберкулезу в стране оценивается как весьма напряженная.
Одной из причин этого являются рост доли туберкулеза с множественной лекарственной устойчивостью микобактерий туберкулеза (МЛУ МБТ) и рост доли пациентов с сочетанием туберкулеза и ВИЧ-инфекции, требующих особого подхода к диагностике и лечению.
В настоящей программе представлен современный алгоритм выявления и диагностики туберкулеза. Представлены стандартные подходы к диагностике туберкулеза, которые определены в методических рекомендациях по совершенствованию диагностики и лечения туберкулеза органов дыхания (приказ Минздрава России от 29.12.2014 № 951). Особое внимание уделено современным молекулярно-генетическим методам идентификации возбудителя туберкулеза.

Актуальность программы обусловлена необходимостью освоения современных методов решения профессиональных задач, требующих от врача-специалиста знаний новейших диагностических и терапевтических методик.
Программа ПК «Актуальные вопросы детской кардиологии» призвана познакомить слушателей с научно-обоснованными методами диагностики, лечения, предупреждения осложнений при наиболее распространенных заболеваниях сердечно-сосудистой системы в детском возрасте. В процессе изучения программы слушатели узнают о современных национальных и международных рекомендациях по диагностике и лечению основных кардиологических заболеваний детей.

Дополнительная профессиональная программа повышения квалификации "Гинекология" объемом 144 ак. часа предназначена для повышения квалификации специалистов с высшим медицинским образованием по основной специальности «Акушерское дело», по дополнительным специальностям: УЗИ, Скорая и медицинская помощь, анестезиология и реаниматология, онкология, генетика, эндокринология, дерматовенерология, патологическая анатомия, педиатрия, терапия, неонатология, гигиеническое воспитание, сексология, урология, калопроктология, пластическая хирургия, функциональная диагностика, токсикология.
Цель реализации программы - совершенствование компетенций, необходимых для профессиональной деятельности; повышение профессионального уровня в рамках имеющейся квалификации.
Результатом освоения программы является овладение обучающимися следующими навыками:

Цель: совершенствование
профессиональной компетенции и повышение профессионального уровня в рамках
имеющейся квалификации специалистов с высшим медицинским образованием по основной
специальности «Терапия»/ «Диетология», а также
актуализация и систематизация полученных теоретических и практических знаний.

Дополнительная профессиональная программа повышения квалификации «Автоклавирование в лабораториях и медицинских учреждениях» предназначена для повышения квалификации медицинских работников, имеющих высшее образование по специальности.
Программа составлена на основе Профессионального стандарта 02.032 «Специалист в области клинической лабораторной диагностики» (утв. приказом Министерства труда и социальной защиты Российской Федерации от 14 марта 2018 года №145н).

Древнее изречение «кто хорошо диагностирует, тот хорошо лечит», определяющее сущность медицины, в настоящее время относится к патологоанатому, так как многие диагностические задачи решаются на основе результатов прижизненного морфологического исследования биоптатов и операционного материала. В этих случаях патологоанатом вместе с клиницистом определяет судьбу больного и отвечает за весь ход лечебного процесса.

В настоящее время прямой и косвенный социально-экономический ущерб от инфекционных болезней остается колоссальным; инфекционная патология продолжает занимать одну из главных позиций в структуре причин преждевременной смертности населения; особое место здесь всегда отводится карантинным, особо опасным и пандемическим инфекциям прошлого, настоящего и будущего.
Несмотря на огромные усилия международного сообщества, серьезными факторами, препятствующим решению проблемы контроля над контагиозными болезнями, выступают: высокая изменчивость инфекционных агентов, сложности в реализации точной экспресс-диагностики и трудности с выбором адекватной и высоко эффективной терапии.
В свете этого следует всегда помнить те выдающиеся успехи, которые удалось достичь в борьбе с враждебными человеку микроорганизмами.
В связи с этим, повышение квалификации специалистов в этой области особенно актуально. В процессе изучения программы, обучающиеся познакомятся с актуальными вопросами по данному направлению.

Программа профессиональной переподготовки «Клиническая лабораторная диагностика в ветеринарии» предназначена для специалисты с высшим образованием по специальностям: «Ветеринария», «Ветеринарно-санитарная экспертиза».
Цель программы – изучение современных методов и последовательных этапов лабораторной диагностики в ветеринарии с целью распознавания болезней и осуществления лечебно-профилактических мероприятий.

Термином «Нейродинамика» принято обозначать совокупность ряда свойств нервной системы, ответственных за работоспособность нервных клеток. Процессы нейродинамики – это процессы возбуждения и торможения, баланс этих процессов, позволяет обеспечить нормальную работоспособность нервной системы и мозга. Движение активирует множество механических и физиологических реакций в нервных тканях. Эти реакции включают нервное скольжение, повышение давления, удлинение, напряжение и изменения внутринейронной микроциркуляции, аксональный транспорт и импульсный трафик. При движении тела в организме происходит множество реакций различного свойства в дополнение к напряжению, и эту особенность можно задействовать для избавления от болевого синдрома.
Проблемы опорно-двигательного аппарата обусловлены не только состоянием мышц, суставов, костей, сухожилий, но и изменениями в нервах и нервных оболочках.
В рамках данной программы слушатели познакомятся с особенностями использования данного метода при лечении различных заболеваний.
В процессе изучения программы, обучающиеся познакомятся с актуальными вопросами по данному направлению.

Актуальность программы обусловлена необходимостью освоения современных методов решения профессиональных задач, требующих от врача-специалиста знаний новейших диагностических и терапевтических методик.
Γоловная боль (ΓБ, цефалгия) - одна из наиболее распространенных жалоб на приеме невролога и врача общей практики (ВОП); ΓБ входят в десятку самых частых причин нетрудоспособности в Европе. В процессе изучения программы, обучающиеся познакомятся с актуальными вопросами по данному направлению педиатрия.
Содержание программы построено по модульному принципу.
Представленная ДПП ПК содержит образовательные модули: общие принцигы диагностики цефалгий (4 ак.ч.), диагностика и лечение мигрени (8 ак.ч.), головная боль напряжения (8 ак.ч.), кластерная головная боль (8), пароксизмальная гемикрания (6), итоговое тестирование (2 ак.ч.).
Модули подразделяются на темы, каждая тема − на элементы. По окончании изучения курса предусмотрена аттестация в форме тестирования. Трудоемкость программы составляет 36 академических часов. Реализация обучения предполагается с использованием ДОТ и ЭО.
Требования к поступающему для обучения на программу слушателю:
Наличие высшего медицинского образования по специальностям по специальностям
«Терапия», «Неврология», «Общая врачебная практика (семейная медицина)».

В настоящее время наблюдается стремительное развитие и совершенствование лабораторных методов диагностики аллергических заболеваний – одной из составных частей иммуноанализа. Все возрастающее влияние на методы лабораторной диагностики оказывают такие дисциплины, как химия высокомолекулярных соединений, клеточная и генная инженерия, под влиянием которых меняются технологии иммунноанализа. Диагностические потребности приводят к тому, что расширяется число объектов исследований.
В связи с этим возникает потребность в подготовке специалистов на современном уровне, в том числе работающих в амбулаторно-поликлинических учреждениях. В процессе изучения программы, обучающиеся познакомятся с актуальными вопросами по данному направлению. В содержании программы (в учебном плане) представлены образовательные модули:
- Аллергические заболевания. Основные понятия;
- Методы диагностики аллергических заболеваний.
Модули подразделяются на темы, каждая тема − на элементы. По окончании изучения курса предусмотрена аттестация в форме тестирования. Трудоемкость программы составляет 36 академических часов. Реализация обучения предполагается с использованием ДОТ и ЭО.

Актуальность дополнительной профессиональной программы повышения квалификации «Терапия» обусловлена тем, что «терапия» как специальность остается наиболее массовой и востребованной в практическом здравоохранении. Недостаточные или неполные знания в области терапии, а также необходимость оказания медицинской помощи, данной категории больных, может вызывать определенные трудности в ранней диагностике, лечении и профилактике заболеваний терапевтического профиля. Обучение в рамках программы «Терапия», дает возможность усовершенствовать знания обучающихся об этиологии, патогенезе, клинике, современных методах диагностики, лечения и профилактике наиболее распространенных заболеваний и состояний; знакомит с особенностями течения болезни у коморбидных пациентов, вызывающей трудности при установлении диагноза; углубляет и расширяет знания о новых методах лечения; определяет показания к консультации у специалистов, совершенствует практические навыки в отношении обследования, проведения дифференциального диагноза, экспертизы трудоспособности и диспансеризации данной категории больных совместно с узко-профильными специалистами.
В связи с этим, потребность в усовершенствовании знаний и навыков врача-терапевта на современном уровне, в том числе, работающего и в амбулаторно поликлинических учреждениях и стационаре, является крайне актуальной.
Настоящая программа предназначена для повышения квалификации врачей терапевтов, амбулаторно-поликлинического и стационарного звена здравоохранения.
Требования к поступающему для обучения на программу слушателю:
Наличие высшего медицинского образования по специальностям: «Терапия», «Лечебное дело», «Общая врачебная практика (семейная медицина)».

Задача учебного курса — совершенствование профессиональной компетенции и повышение профессионального уровня в рамках имеющейся квалификации «Организация здравоохранения и общественное здоровье», а также актуализация и систематизация полученных теоретических и практических знаний в области менеджмента в здравоохранении.

Гистологическое исследование проводится в случаях, когда при помощи других методов не удается точно установить диагноз. Изучение ткани позволяет выяснить характер патологического процесса – это может быть воспаление, гиперплазия, дистрофия или новообразование. В последнем случае патоморфолог выясняет вид опухоли, что позволяет определиться с лечебной тактикой.
Гистологическое исследование помогает выяснить степень распространения процесса или проверить эффективность проведенного лечения. При онкологических заболеваниях целью гистологии может стать определение объема хирургического вмешательства.
Гистологическое исследование дает научное представление о материальной сущности болезни: ее становлении, динамике развития, анатомических и гистологических изменениях в органах и тканях, компенсаторно-приспособительных процессах и исходах.
Основное внимание в настоящей программе уделяется изучению морфологических изменений при патологических процессах и заболеваниях по их патологоанатомическим и гистологическим проявлениям. В процессе изучения программы, обучающиеся познакомятся с актуальными вопросами по данному направлению. ДПП ПК содержит образовательные модули:
- Общие вопросы гистологии;
- Гистологическая техника лабораторных исследований при болезнях сердечно-сосудистой системы;
- Гистологическая техника лабораторных исследований при болезнях желудочно-кишечного тракта;
- Гистологическая техника лабораторных исследований при инфекционных и паразитарных болезнях;
- Гистологическая техника лабораторных исследований при болезнях опорно-двигательного аппарата.

Цель дополнительной профессиональной программы повышения квалификации медицинских работников «Организация здравоохранения и общественное здоровье» (504 ак.ч.) заключается в совершенствовании профессиональных компетенций по организации, экономики, управления и информационно-аналитического обеспечения здравоохранения. Программа разработана для управленческих кадров системы здравоохранения – врачей по специальности «организация здравоохранения и общественное здоровье».
Программа проводится с применением дистанционных образовательных технологий (ДОТ)
Размещена на портале НМФО
После успешного освоения программы начисляются баллы НМО
Подходит для получения периодической аккредитации

Курс "Репродуктология" предназначен для профессионального развития и повышения квалификации специалистов в области гинекологии и репродуктивного здоровья. Он предоставляет возможность актуализировать и систематизировать полученные ранее знания и навыки в области репродуктологии.
Курс имеет заочную форму обучения, что позволяет участникам гибко планировать свое время и осваивать материалы удаленно. Для этого используются дистанционные образовательные технологии и электронное обучение, которые обеспечивают доступ к учебным материалам и коммуникацию с преподавателями.
Продолжительность программы составляет 144 академических часа, что позволяет освоить все необходимые теоретические и практические аспекты репродуктологии. Курс рассчитан на 20 дней, при условии не более 8 академических часов обучения в день.
Основная цель курса - совершенствование профессиональной компетенции и повышение уровня квалификации врачей-гинекологов-репродуктологов. В рамках обучения участники получат актуальные знания и навыки в области репродуктивного здоровья, а также научатся применять их на практике.
Курс "Репродуктология " предоставляет возможность специалистам углубить свои знания в области репродуктивного здоровья, улучшить качество медицинской помощи и повысить уровень профессионализма.

Учебный курс предназначен для врачей, желающих повысить свою квалификацию в области лабораторной диагностики паразитарных заболеваний. Курс предоставляет основные знания и навыки в области определения и идентификации паразитов, а также методов лабораторной диагностики и микроскопии. Участники курса изучат различные виды паразитов, их жизненные циклы и способы передачи, а также основные методы лабораторной диагностики, включая микроскопические и иммунологические методы.

В процессе изучения программы, обучающиеся познакомятся с актуальными вопросами по данному направлению. В учебном плане программы представлены образовательные модули:
- Эндометриоз у девочек – подростков;
- Преемственность амбулаторного звена и стационара в лечении эндометриоза;
- Малоинвазивные органосохраняющие технологии в лечении эндометриоза;
- Эндоваскулярная хирургия;
- Фуз-абляция миомы матки.
Каждый модуль подразделяется на темы, каждая тема − на элементы. По окончании изучения курса предусмотрена аттестация в форме тестирования. Трудоемкость программы составляет 36 академических часов. Реализация обучения предполагается с использованием ДОТ и ЭО.

Высокая информативность ультразвуковых исследований как диагностических методов общеизвестна. Они широко используются как для диагностики сложных заболеваний, так и при различных скрининговых исследованиях, профилактических медицинских осмотрах, диспансеризации.
Специалистам - врачам ультразвуковой диагностики необходимы самые современные знания о физико-технических основах ультразвука, об особенностях ультразвуковой диагностики различных органов и систем. В связи с этим потребность в подготовке специалистов на современном уровне является особенно необходимой.
В связи с вышеперечисленным, предлагаем программу повышения квалификации для врачей ультразвуковой диагностики.
В рамках программы для изучения слушателям предлагаются образовательные модули, указанные в Учебном плане, представленном ниже. По окончании изучения курса предусмотрена аттестация в форме тестирования. При условии успешной сдачи итогового теста и завершении курса, обучающийся получает удостоверение о повышении квалификации установленного образца. Трудоемкость программы составляет 144 академических часа, что позволит вам успешно пройти периодическую аккредитацию в соответствии с приказом Министерство здравоохранения Российской Федерации от 28 октября 2022 г. №709н «Об утверждении положения об аккредитации специалистов».

Медицинские осмотры работников, занятых на тяжелых работах и на работах с вредными и опасными условиями труда — один из важнейших компонентов профилактики профессиональных заболеваний и производственного травматизма. В марте 2022 года законодательство по медосмотрам претерпело изменения, поэтому в курсе представлена информация, как организовать медосмотры по-новому: приводим подробный алгоритм действий, пишем о нюансах работы с медорганизацией, необходимых документах, ответственности за отсутствие медосмотров и многом другом.

Программа направлена на получение компетенций, необходимых для выполнения нового вида профессиональной деятельности по специальности «Ультразвуковая диагностика».
Проведение обучающего курса по перинатальной ультразвуковой диагностике для врачей, имеющих непосредственное отношение к ведению беременности и внутриутробной диагностике, призвано значительно усовершенствовать раннее полученные знания.
Данная подготовка позволит специалистам правильно выбрать тактику ведения беременности, провести своевременное внутриутробное лечение, определить место и метод родоразрешения, а также последующую безопасную маршрутизацию новорожденного в специализированный стационар.

Актуальность дополнительной программы повышения квалификации «Профилактика производственного травматизма и профессиональных заболеваний» связана с тем, что производственный травматизм и профессиональные заболевания являются не только медицинской, но и важной социальной проблемой. По совместным отчётам Всемирной организации здравоохранения(ВОЗ) и Всемирной организации труда(МОТ) за 2021 год 81 % смертных случаев приходится на неинфекционные заболевания. Чаще всего к смертельному исходу приводила острая хроническая легочная недостаточность, инсульт и ишемическая болезнь сердца. 19 % смертных случаев пришлось на производственные травмы. Таким образом, приведённые данные свидетельствуют о необходимости действий по созданию более здоровых, безопасных, стабильных и социально справедливых условий труда, прежде всего за счет укрепления здоровья на рабочем месте и развития служб охраны труда. Кроме того, 1 сентября 2022 года вступают в силу постановление No 2464, регламентирующее порядок обучения и организацию контроля знаний по охране труда.

Актуальность дополнительной программы повышения квалификации «Оборот наркотических средств и психотропных веществ в медицинских организациях» обусловлена изменениями в законодательстве по обороту наркотических средств и психотропных веществ. С 01 марта 2022 вступили в силу новые федеральные нормативные акты, регулирующие вопросы порядок назначения, отпуска, хранения, уничтожения, предметно-количественного учёта наркотических средств и психотропных веществ. Дополнительная профессиональная программа повышения квалификации «Оборот наркотических средств и психотропных веществ в медицинских организациях» предназначена для повышения квалификации специалистов со средним профессиональным образованием и разработана на основе профессионального стандарта 02.069 «Cпециалист по организации сестринского дела».
Дополнительная профессиональная программа повышения квалификации «Оборот наркотических средств и психотропных веществ в медицинских организациях» - совокупность документов, определяющих организацию образовательного процесса, в том числе цели, планируемые результаты повышения квалификации, учебный план, календарный учебный график, рабочие программы дисциплин (тем), организационно-педагогические условия, формы аттестации, оценочные материалы.

ДПП ПК «Диагностические возможности стресс-электрокардиографии и холтеровского мониторирования в клинике внутренних болезней»,
36 ак.ч.
Электрокардиография - незаменимый метод диагностики сердечных заболеваний. Широкое применение в практике врачей стресс-ЭКГ (ВЭМ-проба, тредмил-тест) и ХМЭКГ в качестве отдельно взятых исследований или их комплексное использование, как одного из ведущих способов диагностики и дифференциальной диагностики сердечно-сосудистых заболеваний; расширение и совершенствование функциональных возможностей ЭКГ-методов исследования сердца в аспекте изучения и визуализации показателей не только сердечно-сосудистой системы, но и центральной гемодинамики, периферического кровообращения, центральной и периферической нервной системы в клинике внутренних болезней у пациентов различных возрастных групп требует специальной подготовки врачей. Это определяет актуальность темы «Диагностические возможности стресс-электрокардиографии и холтеровского мониторирования в клинике внутренних болезней».

В представленной программе повышения квалификации рассматриваются основные вопросы оказания неотложной помощи при критических ситуациях в акушерско-гинекологической практике с учетом современных достижений науки, клинической медицины и фармации, клинических протоколов Российской Федерации и международных профессиональных сообществ врачей. Настоящая программа предназначена для повышения квалификации специалистов с высшим медицинским образованием по специальностям: Акушерство и гинекология, Анестезиология-реаниматология, Лечебное дело, Трансфузиология, Хирургия.

Концепция развития здравоохранения и медицинской науки предусматривает переход к системе организации и оказания медицинской помощи по принципу единого лечащего врача, ответственного за состояние здоровья и профилактику заболеваний, допуск к профессии и иным видам деятельности, связанным с воздействием вредных факторов либо повышенной опасностью для пациента и окружающих.
С 1 апреля 2021 вступил в силу новый порядок проведения обязательных предварительных и периодических медицинских осмотров работников, утвержденный приказом Министерства здравоохранения РФ от 28.01.2021 №29н проведения медицинских осмотров.
Проводить медосмотр по новым правилам – это не только правильное оформление документов. Медицинские осмотры нацелены на выявление заболеваний на ранней стадии, предупреждение профзаболеваний. Право на осуществление экспертизы связи заболеваний с профессией предоставляется государственным (муниципальным) центрам профпатологии (Минздрава России на базе НИИ медицины труда РАМН, территориальным в субъектах РФ и ведомственным) и научно-исследовательским институтам системы Минздрава России, РАМН, имеющим в своей структуре клиники профпатологии, при наличии лицензии на данный вид деятельности.
В процессе изучения программы, обучающиеся познакомятся с актуальными вопросами по данному направлению.
Дополнительная профессиональная программа повышения квалификации по циклу «Обследование и установление диагноза терапевтических больных» предназначена для повышения квалификации медицинских работников, имеющих высшее специальное образование по специальностям «Лечебное дело», подготовку в интернатуре/ординатуре по специальности «Терапия», дополнительное профессиональное образование - профессиональная переподготовка по специальности «Терапия» при наличии подготовки в ординатуре по специальности «Общая врачебная практика (семейная медицина)».
Содержание Программы соответствует широте полномочий и ответственности работника соответствующего уровня профессиональной подготовки и представляет собой совокупность требований, предъявляемых к специалисту, работающему в должности врача терапевта в амбулаторном и/или стационарном подразделениях.

Дополнительная профессиональная программа «Внутриаптечный контроль качества лекарственных средств» предназначена для повышения квалификации специалистов с высшим профессиональным образованием по специальности «Фармация» и прошедших интернатуру/ординатуру по специальности «Фармацевтическая химия и фармакогнозия.
Дополнительная программа повышения квалификации реализуется в заочной форме.
Продолжительность обучения- 36 ак. часов.

Дополнительная профессиональная программа «Клиническая лабораторная диагностика» предназначена для повышения квалификации специалистов с высшим профессиональным медицинским образованием-специалитет по одной из специальностей: «Лечебное дело», «Педиатрия», «Стоматология», «Медико-профилактическое дело», «Медицинская биохимия», «Медицинская биофизика», «Медицинская кибернетика», «Бактериология», а также подготовку в интернатуре/ординатуре по специальности «Клиническая лабораторная диагностика».

Дополнительная профессиональная программа повышения квалификации по циклу "Акушерство и гинекология" объемом 144 ак. часа предназначена для повышения квалификации специалистов с высшим медицинским образованием по основной специальности «Акушерское дело», по дополнительным специальностям: УЗИ, Скорая и медицинская помощь, анестезиология и реаниматология, онкология, генетика, эндокринология, дерматовенерология, патологическая анатомия, педиатрия, терапия, неонатология, гигиеническое воспитание, сексология, урология, калопрактология, пластическая хирургия, функциональная диагностика, токсикология.
Цель реализации программы - совершенствование компетенций, необходимых для профессиональной деятельности; повышение профессионального уровня в рамках имеющейся квалификации.
Результатом освоения программы является овладение обучающимися следующими навыками:

Дополнительная профессиональная программа «Организация здравоохранения и управление клинической лабораторией» предназначена для повышения квалификации, директоров, заведующих клинико-диагностическими, генетическими, бактериологическими, вирусологическими, микробиологическими, бактериологическими лабораториями по организации работы и управлению лабораторией.
Актуальность и практическая значимость дополнительной профессиональной программы связана со специфическими особенностями работы заведующих, руководителей и начальников клинических лабораторий в сравнении с другими клиническими подразделениями медицинской организации, включая разделы по персональному допуску к работе в клинико-диагностической лаборатории, менеджменту, обеспечению качества, логистике организации потоков биоматериала для лабораторных исследований, работе с персоналом, соблюдению санитарно-эпидемиологических требований; документообороту структурного подразделения медицинской организации.
Особенности реализации дополнительной профессиональной программы
повышения квалификации заключаются в реализации программы с применением
дистанционных образовательных технологий и электронного обучения. Для
проведения семинарских занятий используется формат асинхронной веб-конференции.
После успешного завершения обучения по программе повышения квалификации выдается удостоверение о повышении квалификации.
Дополнительная профессиональная программа реализуется в заочной форме, рассчитана на 72 академических часа.
Форма итогового контроля - тестирование.

Дополнительная профессиональная программа повышения квалификации «Управление системой качества выполнения клинических лабораторных исследований» предназначена для повышения квалификации специалистов с высшим образованием. Программа повышения квалификации разработана в соответствии с профессиональным стандартом 02.032 Специалист в области клинической лабораторной диагностики (утв. Приказ Министерства труда и социальной защиты Российской Федерации от 14 марта 2018 года № 142н).

Дополнительная профессиональная программа повышения квалификации «Вопросы трансфузиологии и иммуногематологии» предназначена для повышения квалификации специалистов с высшим медицинским образованием.
Актуальность и практическая значимость дополнительной профессиональной программы обусловлена развитием клинической иммуногематологии и клинической трансфузиологии, требующих от врачей-специалистов знания современных методов трансфузиологической гемокоррекции.
Ни один раздел современной науки не обходится без иммунологических исследований. В гематологии эти исследования ведутся по следующим основным направлениям: исследование особенностей иммунного статуса больных, где используются общеиммунологические методы; иммунофенотипирование лейкозной клетки, позволяющее уточнить диагноз; иммуногематологические исследования, изучающие антигены и антитела составных частей крови.
Настоящая программа будет способствовать освоению современных методов решения профессиональных задач, требующих от врача-специалиста знаний новейших диагностических и терапевтических методик.
Важность приобретения знаний и навыков по вопросам трансфузиологии и иммуногематологии определяется требованиями нормативных документов Министерства здравоохранения РФ по профилактике посттрансфузионных реакций и осложнений при трансфузиях гемокомпонентов пациентам лечебно-профилактических учреждений.
Особенности реализации дополнительной профессиональной программы повышения квалификации заключаются в реализации программы с применением дистанционных образовательных технологий и электронного обучения. Для проведения семинарских занятий используется формат асинхронной веб-конференции.
После успешного завершения обучения по программе повышения квалификации выдается удостоверение о повышении квалификации.
Дополнительная профессиональная программа реализуется в заочной форме, рассчитана на 36 академических часов.
Форма итогового контроля - тестирование.

Дополнительная профессиональная программа повышения квалификации «Организация службы крови в РФ. Донорство крови» предназначена для повышения квалификации специалистов с высшим медицинским образованием.
Актуальность и практическая значимость дополнительной профессиональной программы связана с необходимостью постоянного совершенствования профессиональных компетенций специалистов в связи с изменением нормативно-правового регулирования организации службы крови, трансфузиологической и гематологической помощи, а также процессов формирования донорства в Российской Федерации; необходимостью непрерывного обеспечения надлежащего уровня качества оказываемой населению медицинской помощи, в том числе в части безопасности предоставляемых медицинских услуг, как одного из основных компонентов качества медицинской помощи.
Важность приобретения знаний и навыков по иммуногематологической диагностике определяется требованиями нормативных документов Министерства здравоохранения РФ по профилактике посттрансфузионных реакций и осложнений при трансфузиях гемокомпонентов пациентам лечебно-профилактических учреждений.
Особенности реализации дополнительной профессиональной программы повышения квалификации заключаются в реализации программы с применением дистанционных образовательных технологий и электронного обучения. Для проведения семинарских занятий используется формат асинхронной веб-конференции.
После успешного завершения обучения по программе повышения квалификации выдается удостоверение о повышении квалификации.
Дополнительная профессиональная программа реализуется в заочной форме, рассчитана на 36 академических часов.
Форма итогового контроля - тестирование.

Дополнительная
профессиональная программа повышения квалификации «Инфузионная трансфузиология»
предназначена для повышения квалификации специалистов с высшим медицинским
образованием
Актуальность и практическая значимость дополнительной профессиональной программы связана с необходимостью постоянного совершенствования профессиональных компетенций специалистов в связи с появлением новых представлений об антигенной системе AB0, Резус, антигенных системах крови и совершенствованием методик современных иммуногематологических исследований.
Важность приобретения знаний и навыков по иммуногематологической диагностике определяется требованиями нормативных документов Министерства здравоохранения РФ по профилактике посттрансфузионных реакций и осложнений при трансфузиях гемокомпонентов пациентам лечебно-профилактических учреждений.
Особенности реализации дополнительной профессиональной программы повышения квалификации заключаются в реализации программы с применением дистанционных образовательных технологий и электронного обучения. Для проведения семинарских занятий используется формат асинхронной веб-конференции.
После успешного завершения обучения по программе повышения квалификации выдается удостоверение о повышении квалификации.
Дополнительная профессиональная программа реализуется в заочной форме, рассчитана на 36 академических часов.
Форма итогового контроля - тестирование.

Актуальность дополнительной профессиональной
программы повышения квалификации «Стандарты качества деятельности
фармацевтических организаций» обусловлена изменениями в фармацевтическом
законодательстве, вступившими в силу с 01 января 2021 года. Знание обновлённых
положений позволит организовать работу фармацевтической организации в
соответствии с требованиями и избежать возможных штрафных санкций со стороны
контролирующих органов.

Дополнительная профессиональная программа по циклу «Электрокардиография в практике врача» объемом 36 ак. часа является нормативно-методическим документом, регламентирующим содержание и организационно-методические формы обучения по профилю «Кардиология» в дополнительном профессиональном образовании врачей и предназначена для специалистов с высшим медицинским образованием по основной специальности «Кардиология», по дополнительным специальностям: Авиационная и космическая медицина, Анестезиология-реаниматология, Детская кардиология, Детская хирургия, Лечебная физкультура и спортивная медицина, Лечебное дело, Общая врачебная практика (семейная медицина), Организация здравоохранения и общественное здоровье, Педиатрия, Ревматология, Сердечно-сосудистая хирургия, Скорая медицинская помощь, Терапия, Токсикология, Торакальная хирургия, Ультразвуковая диагностика, Физическая и реабилитационная медицина, Функциональная диагностика, Хирургия, Эндокринология.
Цель реализации программы заключается в совершенствовании профессиональных навыков специалистов с высшим медицинским образованием, необходимым для регистрации и оценки результатов электрокардиографии.
Основные задачи программы:
- совершенствование знаний и компетенций об оказании медицинской помощи пациентам при заболеваниях и (или) состояниях сердечно-сосудистой системы;
- совершенствование знаний и компетенций при проведении обследования пациентов при заболеваниях и (или) состояниях сердечно-сосудистой системы с целью постановки диагноза;
- совершенствование знаний и компетенций по вопросам обеспечения требований безопасности при оказании медицинской помощи.

Дополнительная профессиональная программа повышения квалификации «Управление системой качества выполнения клинических лабораторных исследований» предназначена для повышения квалификации специалистов с высшим образованием. Программа повышения квалификации разработана в соответствии с профессиональным стандартом 02.032 Специалист в области клинической лабораторной диагностики (утв. Приказ Министерства труда и социальной защиты Российской Федерации от 14 марта 2018 года № 142н).

Дополнительная профессиональная программа по циклу «Управление качеством клинических лабораторных исследований» предназначена для повышения квалификации специалистов с высшем профессиональное образование (академическая квалификация: магистр или специалист) по специальности «Биология», «Биохимия», «Биофизика», «Генетика», «Микробиология», «Фармация» и дополнительное профессиональное образование в соответствии с направлением профессиональной деятельности без предъявления требований к стажу работы.

Дополнительная профессиональная программа повышения квалификации «ПЦР-диагностика SARS-Cov-2 (Covid-19) и других инфекционных заболеваний» предназначена для повышения квалификации специалистов в области клинической лабораторной диагностики

На основании данных официальной статистики Министерства здравоохранения «Заболеваемость населения России. Статистические материалы» и данных ФГБУ «Центральный научно-исследовательский институт организации и информатизации здравоохранения» Минздрава России за 2000-2018 гг. общее число мужчин с бесплодием увеличилось с 22348 до 47886 человек (+114%), отмечен прирост на 82% больных с первично установленным мужским бесплодием. Оценка патофизиологических процессов в организме пациента, уточнение диагноза и выбор метода лечения происходит, в том числе на основании результатов клинических лабораторных исследований. Поэтому врачу КЛД, выполняющему клинические лабораторные исследования четвертой категории сложности, необходимо постоянно усовершенствовать навыки, знания и умения. Согласно профессиональному стандарту 02.032 выполнение спермограммы требует от специалиста непрерывного повышения квалификации.

Изучение микроорганизмов всегда было актуальным направлением медицины, поэтому врачи в данной области весьма востребованы. А их работа с пациентами важна для сохранения жизни на земле. В данном курсе Вы познакомитесь с методом исследования - бактериология в медицине. Увидите в чем преимущество современной лабораторной диагностики в Компании Ситилаб.
В данном курсе 4 раздела из которых вы узнаете:
После курса можно проверить свои знания в тестировании, которое сформировано на информации полученной в данном курсе.
Успешного обучения!

Медицинская лаборатория – это сложная система, включающая огромное количество разнородных процессов и процедур. Национальные и международные стандарты в области качества клинических лабораторных исследований, а также нормативное регулирование процессов функционирования лаборатории являются той базой знаний, на которую должен опираться руководитель клинико-диагностической лаборатории. Руководство лаборатории должно определить и документально оформлять политику, цели и обязательства в области качества, что определяет актуальность программы «Контроль качества деятельности лаборатории и ведения документации».
Дополнительная профессиональная программа повышения квалификации «Контроль качества деятельности лаборатории и ведения документации» разработана в соответствии с профессиональным стандартом 02.032 "Специалист в области клинической лабораторной диагностики" (Приказ Министерства труда и социальной защиты Российской Федерации от 14 марта 2018 года № 145 н).
Рост инфекционных заболеваний, опасность возникновения и распространения госпитальных инфекций, широкое применение в лечебной практике антибактериальных препаратов и изменение структуры микрофлоры в формировании инфекционных процессов требуют новых подходов к организации микробиологической диагностики в лечебно-профилактических учреждениях.
Актуальность программы повышения квалификации «Контроль качества в бактериологической лаборатории» обусловлена необходимостью улучшения организации работы лабораторий клинической микробиологии (бактериологии), повышения уровня и эффективности микробиологической диагностики, совершенствования профилактических и лечебно-диагностических мероприятий по снижению госпитальных инфекций и гнойно-воспалительных осложнений у больных в лечебно-профилактических учреждениях.
Дополнительная профессиональная программа повышения квалификации «Контроль качества в бактериологической лаборатории» разработана в соответствии с профессиональным стандартом 02.032 «Специалист в области клинической лабораторной диагностики» (Приказ Министерства труда и социальной защиты Российской Федерации от 14 марта 2018 года № 145 н) и Приказом Министерства здравоохранения и медицинской промышленности Российской Федерации от 19 января 1995 г. № 8 «О развитии и совершенствовании деятельности лабораторий клинической микробиологии (бактериологии) лечебно-профилактических учреждений».

Рак шейки матки (РШМ) занимает второе место среди злокачественных опухолей женских репродуктивных органов, уступая лишь раку молочной железы, первое место по сокращению лет жизни женщины и четвертое место в структуре онкологической заболеваемости женского населения в мире. Важно отметить, что в последние годы в РФ обозначился рост заболеваемости раком шейки матки у женщин в возрастной группе до 29 лет. Надежным методом ранней профилактики рака шейки матки является цервикальный скрининг. Своевременная цитологическая диагностика предопухолевых изменений и РШМ позволяет принять меры для предотвращения роста заболеваемости. Врачу КЛД, выполняющему цитологические исследования, необходимо постоянно усовершенствовать навыки, знания и умения для качественной диагностики цервикальной патологии.
Ссылка на источник фото (https://npzhr.ru/800/600/https/cf2.ppt-online.org/files2/slide/u/u8PYncheEmoFAKRkfMwdgr039DQZWIBHVGX4z1sSq/slide-37.jpg)

Дополнительная профессиональная программа по циклу "«Электрокардиография в практике врача»" объемом 18 ак. часа является нормативно-методическим документом, регламентирующим содержание и организационно-методические формы обучения по профилю «Кардиология» в дополнительном профессиональном образовании врачей и предназначена для специалистов с высшим медицинским образованием по основной специальности «Кардиология», по дополнительным специальностям: Авиационная и космическая медицина, Анестезиология-реаниматология, Детская кардиология, Детская хирургия, Лечебная физкультура и спортивная медицина, Лечебное дело, Общая врачебная практика (семейная медицина), Организация здравоохранения и общественное здоровье, Педиатрия, Ревматология, Сердечно-сосудистая хирургия, Скорая медицинская помощь, Терапия, Токсикология, Торакальная хирургия, Ультразвуковая диагностика, Физическая и реабилитационная медицина, Функциональная диагностика, Хирургия, Эндокринология.
Цель реализации программы заключается в совершенствовании профессиональных навыков специалистов с высшим медицинским образованием, необходимым для расшифровке и оценки результатов электрокардиографии.
Основные задачи программы:
- совершенствование знаний и компетенций об оказании медицинской помощи пациентам при заболеваниях и (или) состояниях сердечно-сосудистой системы;
- совершенствование знаний и компетенций при проведении обследования пациентов при заболеваниях и (или) состояниях сердечно-сосудистой системы с целью постановки диагноза;
- совершенствование знаний и компетенций по вопросам обеспечения требований безопасности при оказании медицинской помощи.

Врачи-онкологи используют лабораторную диагностику для постановки и уточнения диагноза онкологического пациента. Часто цитологический и гистологический биоматериал содержит недостаточную информацию для врача-морфолога, что приводит к расхождению клинических и морфологических данных. Это мешает постановке верного диагноза и приводит к некорректной терапии.
Предлагаем разобраться в актуальных методах лабораторной диагностики онкологических заболеваний, правилах взятия, хранения, отправки материала и разобраться в ошибках преаналитического этапа.

Дополнительная профессиональная программа повышения квалификации «Актуальные вопросы правового регулирования в здравоохранении» предназначена для повышения квалификации специалистов с высшим медицинским, юридическим либо другим профессиональным образованием, а также на руководителей или менеджеров организаций и их структурных подразделений, осуществляющих профессиональную деятельность в сфере здравоохранения, а также на всех иных лиц, интересующихся правоотношениями, складывающимися в сфере оказания медицинской помощи.
Актуальность и практическая значимость дополнительной профессиональной программы связана со структурными изменениями, происходящими в системе здравоохранения Российской Федерации. В связи с чем, приоритет получают такие направления, как: совершенствование законодательства в сфере охраны здоровья; модернизация нормативно-правового регулирования в целях противодействия коррупции в сфере здравоохранения, предусматривающее в том числе: совершенствование механизмов выявления и устранения угроз, связанных с коррупциогенными факторами и неоказанием либо несвоевременным оказанием медицинской помощи больным; формирование системы защиты прав застрахованных лиц в сфере обязательного медицинского страхования и др. (Указ Президента Российской Федерации от 6 июня 2019 года N 254 «О Стратегии развития здравоохранения в Российской Федерации на период до 2025 года»).
Особенности реализации дополнительной профессиональной программы повышения квалификации заключаются в реализации программы с применением дистанционных образовательных технологий и электронного обучения. Для проведения семинарских занятий используется формат асинхронной веб-конференции.
После успешного завершения обучения по программе повышения квалификации выдается удостоверение о повышении квалификации.
Дополнительная профессиональная программа реализуется в заочной форме, рассчитана на 36 академических часов.
Форма итогового контроля - тестирование.

Актуальность дополнительной программы повышения квалификации «Оказание медицинской помощи пациентам с доброкачественными новообразованиями кожи» обусловлена снижением выявляемости онкологических заболеваний в период пандемии, либо выявление на поздних стадиях. Введение локдаунов привело к снижению числа профилактических осмотров, невозможности обращения пациентов к врачу в плановом режиме. Кроме
того, с 01 января 2022 вступил в силу Порядок оказания медицинской помощи взрослому
населению при онкологических заболеваниях (Приказ Минздрава России от 19.02.2021 №
116н), который также затрагивает оказание помощи при доброкачественных опухолях. Данная программа повышения квалификации позволит усовершенствовать навыки, необходимые для своевременного и качественного оказания медицинской помощи пациентам с доброкачественными новообразованиями кожи.
Трудоёмкость программы-36 ак.часов.

Актуальность дополнительной профессиональной программы повышения квалификации
«Управление и экономика фармации» заключается в том, что управление и экономика
фармации - одна из профилирующих программ специальности, определяющая
профессиональную подготовку провизоров и формирующая системные знания, умения и
навыки по оказанию квалифицированной, своевременной и доступной фармацевтической
помощи. Особенностью дополнительной программы повышения квалификации является
динамичность дисциплины, которая постоянно меняется под воздействием внешней среды
(политической, экономической, социальной) и требует включения новых знаний
(фармацевтической логистики, фармакоэкономики и др.). В связи с этим необходима
подготовка специалистов в области управления и экономики фармации для оказания
высококвалифицированной медицинской помощи населению.

Актуальность программы дополнительного профессионального образования «Лабораторные методы диагностики заболеваний сердечно-сосудистой системы» обусловлена широким распространением сердечно-сосудистой патологии, обусловливающей высокие показатели заболеваемости и смертности населения. Это положение подчеркивает особое значение и важность организации подготовки высококвалифицированных врачей –кардиологов и других специалистов, оказывающих помощь больным, страдающих сердечно-сосудистыми заболеваниями. Массовая профилактика сердечно-сосудистых заболеваний, предупреждение их прогрессирования, сохранение трудоспособности и продление жизни больных (вторичная профилактика) являются важнейшими задачами современного здравоохранения.
Дополнительная
профессиональная программа повышения квалификации «Кардиология» предназначена
для повышения квалификации специалистов с высшим медицинским образованием и
разработана на основе профессионального стандарта по специальности «Врач-кардиолог»
(утверждён приказом Министерства
труда и социальной защиты Российской Федерации от 14 марта 2018 года № 140 н).

Актуальность дополнительной профессиональной программы повышения квалификации «Регулирование розничной торговли лекарственными средствами» обусловлена изменениями в фармацевтическом законодательстве, вступившими в силу с 01 января 2021 года.
Знание обновлённых положений позволит оптимизировать работу розничной торговли лекарственными препаратами в соответствии с требованиями законодательства и избежать возможных штрафных санкций со стороны контролирующих органов.
Программа «Регулирование розничной торговли лекарственными препаратами» предназначена для повышения квалификации специалистов с высшим фармацевтическим образованием и разработана на основе профессионального стандарта 02.006 «Провизор» (утвержден приказом Министерства труда и социальной защиты Российской Федерации от 09 марта 2016 года № 91н).

Дополнительная профессиональная программа повышения квалификации «Методы обследования неврологического больного с целью установления диагноза» предназначена для повышения квалификации специалистов с высшим медицинским образованием и разработана на основе профессионального стандарта 02.041 «Врач-нефролог» (утверждён приказом Министерства труда и социальной защиты Российской Федерации от 20 ноября 2018 года № 712 н).
Трудоёмкость программы- 18 ак. часов.
Актуальность дополнительной профессиональной
программы повышения квалификации специалистов со высшим медицинским
образованием «Микозы и паразитарные заболевания». Врачи-дерматовенерологи и врачи-инфекционисты должны постоянно
заботиться о повышении своего профессионального уровня. Специалистам следует
быть всегда в курсе новых открытий в области дерматовенерологии и инфекционных
болезней. Законодательные акты, регулирующие деятельность медицинской сферы,
тоже претерпевают постоянные изменения, поэтому необходимо учиться правильно
ориентироваться в них.

Актуальность дополнительной профессиональной программы повышения квалификации специалистов со высшим медицинским образованием «Оказание экстренной медицинской и первой помощи» связана с высокой частотой встречаемости заболеваний и состояний, требующих оказания экстренной медицинской и первой помощи, необходимостью использования особых методов и особой готовности медицинского персонала к оказанию соответствующей помощи, необходимостью точной диагностики в минимально короткие временные сроки и определения лечебной тактики.
Трудоёмкость программы повышения квалификации -18 ак. часов.

По мнению BO3, реабилитация является процессом, направленным на всестороннюю помощь больным и инвалидам для достижения ими максимально возможной при данном заболевании физической, психической, профессиональной, социальной и экономической полноценности. На современном этапе развития отечественного здравоохранения одной из приоритетной целей государственной программы Российской Федерации «Развитие здравоохранения» на период до 2025 года является развитие медицинской реабилитации и совершенствование системы санаторно- курортного лечения, в том числе детей. В связи с этим программа повышения квалификации специалистов, занимающихся вопросами реабилитации, является важной и актуальной.

Дополнительная профессиональная программа по циклу «Эндокринология» предназначена для повышения квалификации специалистов с высшим медицинским образованием по специальности «Лечебное дело», «Педиатрия» и подготовкой в интернатуре и (или) ординатуре по специальности "Эндокринология".

Дополнительная профессиональная программа повышения квалификации «Актуальные вопросы терапевтической стоматологии» предназначена для повышения квалификации специалистов с высшим образованием - специалитет по специальности «Стоматология».
Программа составлена с учётом требований Федерального государственного образовательного стандарта среднего профессионального стандарта «Врач-стоматолог» (утвержден приказом Министерства труда и социальной защиты РФ от 10.05.2016 г. № 227н).

Фармацевтическая деятельность относится к социально значимой отрасли и требует регулярного контроля и надзора со стороны государства во избежание каких-либо нарушений, поскольку это может привести к ухудшению качества лекарственных препаратов, и как следствие, отразиться на здоровье пользующихся ими граждан. Знание изменений и нововведений позволит эффективно управлять фармацевтической организацией.
Дополнительная профессиональная программа повышения квалификации «Управление фармацевтической организацией» предназначена для повышения квалификации специалистов с высшим фармацевтическим образованием и разработана на основе профессионального стандарта 02.012 «Специалист в области управления фармацевтической деятельностью» (утверждён приказом Министерства труда и социальной защиты Российской Федерации от 22 мая 2017 года № 428 н).
Дополнительная профессиональная программа «Дерматовенерология» предназначена для повышения квалификации специалистов с высшим профессиональным образованием по специальности "Лечебное дело" или "Педиатрия" и подготовка в интернатуре и (или) ординатуре по специальности "Дерматовенерология"

Ультразвуковое исследование - ведущий метод в диагностике заболеваний женской половой сферы, поскольку он высокоинформативен и не имеет побочных эффектов. В связи с изменением правил проведения ультразвуковых исследований и порядка оказания медицинской помощи по профилю «акушерство и гинекология» в 2020 году программа повышения квалификации «Методы ультразвукового исследования в гинекологии» актуальна для врачей ультразвуковой диагностики.
Дополнительная профессиональная программа повышения квалификации «Методы ультразвукового исследования в гинекологии» разработана в соответствии с профессиональным стандартом:
- 02.051 «Врач ультразвуковой диагностики» (Утвержден приказом Министерства труда и социальной защиты Российской Федерации от 19 марта 2019 года № 161н).

Дополнительная профессиональная программа повышения квалификации по циклу «Обследование и установление диагноза терапевтических больных» предназначена для повышения квалификации медицинских работников, имеющих высшее специальное образование по специальностям «Лечебное дело», подготовку в интернатуре/ординатуре по специальности «Терапия», дополнительное профессиональное образование - профессиональная переподготовка по специальности «Терапия» при наличии подготовки в ординатуре по специальности «Общая врачебная практика (семейная медицина)».
Содержание Программы соответствует широте полномочий и ответственности работника соответствующего уровня профессиональной подготовки и представляет собой совокупность требований, предъявляемых к специалисту, работающему в должности врача терапевта в амбулаторном и/или стационарном подразделениях.

Дополнительная профессиональная программа повышения квалификации «ПЦР-диагностика и лечение SARS-Cov-2 (Covid-19) и других инфекционных заболеваний» предназначена для повышения квалификации врачей по одной из специальностей укрупненной группы специальностей 31.00.00. «Клиническая медицина».
Программа повышения квалификации разработана на основе Федерального Государственного образовательного стандарта по укрупненной группе специальностей 31.00.00. «Клиническая медицина», Приказа Министерства Здравоохранения Российской Федерации от 08.10.2015 года №707н «Об утверждении Квалификационных требований к медицинским и фармацевтическим работникам с высшим образованием по направлению подготовки «Здравоохранение и медицинские науки» и Приказа Министерства Здравоохранения и Социального развития Российской Федерации №541н от 23 июля 2010 г. «Об утверждении единого квалификационного справочника должностей руководителей, специалистов и служащих», раздел «Квалификационные характеристики должностей работников в сфере здравоохранения».
Дополнительная профессиональная программа повышения квалификации реализуется в заочной форме.

Анализ сведений о деятельности медицинских организаций и здоровье обслуживаемого населения позволяют руководителям здравоохранения выявлять имеющиеся проблемы, принимать управленческие решения, организовывать труд медицинского персонала, улучшать качество медицинского обслуживания. В настоящее время медицинская статистика непрерывно подвергается модернизации. Ежегодное изменение форм федерального статистического наблюдения, введение новых мониторингов, трансформация медицинских информационных систем требует от специалистов, занимающихся медицинской статистикой, непрерывного повышения квалификации.

Дополнительная профессиональная программа повышения квалификации «Современные методы диагностики в гинекологии» предназначена для повышения квалификации специалистов с высшим медицинским образованием и разработана на основе Единого квалификационного стандарта по специальности «Врач акушер-гинеколог» (утверждён приказом Министерства здравоохранения и социальной защиты Российской Федерации от 23 июля 2010 года № 541 н).
Трудоёмкость программы -18 академических часов.
Курс для специалистов органов управления здравоохранением, главных врачей, заместителей главных врачей, руководителей структурных подразделений, членов врачебных комиссий медицинских организаций, а также для врачей-специалистов, участвующих в проведении экспертизы временной нетрудоспособности.
Актуальность
дополнительной программы повышения квалификации «Экспертиза временной
нетрудоспособности» заключается в том, что в сентябре 2022 году вступают в силу
ряд изменений в законодательстве, которые регламентируют выдачу больничных
листков: отменены бумажные больничные листки; предполагается оформление
больничных листков только в электронном виде; изменяются коды причин
нетрудоспособности; претерпели изменения в оформлении поля «Утрата
профессиональной нетрудоспособности». Кроме того, утратил силу приказ № 925 н Минздрава
РФ. Минздрав России приказом от 21 ноября 2021 года № 1089 утвердил новый
Порядок формирования листков нетрудоспособности в форме электронного документа.

Дополнительная профессиональная программа повышения квалификации «Организация деятельности по обращению с медицинскими отходами» предназначена для повышения квалификации специалистов с высшим медицинским образованием.
Актуальность и практическая значимость дополнительной профессиональной программы связана с необходимостью постоянного совершенствования профессиональных компетенций специалистов в связи с изменением нормативно-правового регулирования сферы обращения с медицинскими отходами, необходимостью непрерывного обеспечения надлежащего уровня качества оказываемой населению медицинской помощи, в том числе в части безопасности предоставляемых медицинских услуг, как одного из основных компонентов качества медицинской помощи.
Особенности реализации дополнительной профессиональной программы повышения квалификации заключаются в реализации программы с применением дистанционных образовательных технологий и электронного обучения. Для проведения семинарских занятий используется формат асинхронной веб-конференции.
После успешного завершения обучения по программе повышения квалификации выдается удостоверение о повышении квалификации.
Дополнительная профессиональная программа реализуется в заочной форме, рассчитана на 72 академических часов.
Форма итогового контроля - тестирование.

Для кого: для акушеров-гинекологов и онкологов.
Формат: заочный с использованием дистанционных технологий.
Срок: 10 дней, 72 академических часа.
Результат: удостоверение о повышении квалификации.
Что вы получите:
Идеальный формат для быстрого и качественного профессионального роста.

Для кого этот курс?
Курс предназначен для
психологов, коучей, социальных работников, HR-специалистов и всех, кто
стремится углубить свои навыки в области психологической поддержки.
Подходит как начинающим, так и опытным практикам, желающим интегрировать
коучинг в свою профессиональную деятельность.
Цель программы:
Научить
эффективно сочетать методы коучинга с индивидуальным психологическим
консультированием. Вы освоите инструменты, которые помогут клиентам
раскрывать потенциал, преодолевать внутренние барьеры и достигать целей в
личной и профессиональной жизни.

Курс повышения квалификации по программе: «Десенсибилизация психических
травм с помощью движений глаз в практической работе психолога и
психотерапевта.
Метод «ДПДГ (EMDR)»
Вы научитесь эффективному применению билатеральной стимуляции головного
мозга методом "ДПДГ" (EMDR) в вашей практической работе.

Программа обучения «Безопасные методы и приемы выполнения работ повышенной опасности, к которым предъявляются дополнительные требования в соответствии с нормативными правовыми актами, содержащими государственные нормативные требования охраны труда» (Программа В) (далее по тексту – Программа) разработана в соответствии с требованиями:
- Постановления Правительства РФ № 2464 от 24.12.2021 г. «О порядке обучения по охране труда и проверки знания требований охраны труда»;
- Федерального закона № 273-ФЗ от 29.12.2012 г. «Об образовании в Российской Федерации» (в редакции № 351-ФЗ от 02.07.2021 г.);
- Приказа Минобрнауки России № 499 от 01.07.2013 г. «Порядок организации и осуществления образовательной деятельности по дополнительным профессиональным программам» (в редакции Приказа Минобрнауки России № 1244 от 15.11.2013 г.);
- Методических рекомендаций по разработке основных профессиональных образовательных программ и дополнительных профессиональных программ с учетом соответствующих профессиональных стандартов (утв. приказом Минобрнауки России № ДЛ-1/05вн от 22.01.2015 г.).
Содержание программы представлено пояснительной запиской, календарным учебным графиком, учебным планом, учебно-методическим планом, рабочей программой, организационно-педагогическими условиями реализации программы, списком литературы и методическими пособиями, планируемыми результатами освоения программы, оценочными материалами, обеспечивающими реализацию Программы.
Цель обучения:
Обучение и проверка классификации опасностей, знаний изучения правил охраны труда, способов НПА с государственными нормативными требованиями охраны труда, методов оценки уровня профриска, БМПР повышенной опасности, виды СИЗ, способов организации оказания первой помощи на производстве.
Категории обучающихся:
Специалисты, выполняющие работы повышенной опасности, ответственные за организацию, выполнение и контроль работ повышенной опасности, члены специализированной комиссии по проверке знания требований охраны труда работников, выполняющих работы повышенной опасности.

В настоящее время в связи с интенсивностью развития производственных процессов, появлением и развитием новых видов деятельности, охрана труда приобретает все большее значение. Сегодня потери фактически неотработанного времени из-за травматизма на производстве, дополнительных отпусков и сокращенной продолжительности рабочего времени составляют 92,5 млн. человеко-дней, что равноценно невыходу на работу в течение года 755,3 тыс. человек.
Жизнь и здоровье человека является высшей ценностью. Руководство не должно оставлять без внимания технику безопасности, которая является первоочередной в производстве. Помимо этого, каждый человек на предприятии ценен именно как сотрудник, которые обладает определенным знанием, умением и навыком.
В условиях правильно организованной работы по обеспечению безопасности труда повышается дисциплинированность трудящихся на предприятии, повышается производительность труда, снижается количество несчастных случаев, сбоев оборудования и других нештатных ситуаций, то есть в действительности положительно влияет на производительность предприятия.
Охрана труда, помимо обеспечения безопасности работников во время исполнения ими служебных обязанностей, включает:
– профилактику профессиональных заболеваний;
– организацию полноценного отдыха и питания работников в период перерывов;
– снабжение работников необходимой спецодеждой, гигиеническими средствами, средствами защиты;
– реализацию определенных социальных льгот и гарантий.
Именно правильный подход к организации охраны труда на производстве, правильное применение нематериальных стимуляторов дают работникам чувство стабильности, защищенности их прав и интересов, внимания со стороны руководства к своим работникам.

Важнейшим фактором повышения эффективности производства в любой отрасли является улучшение управления. Совершенствование форм и методов управления происходит на основе достижений научно-технического прогресса, дальнейшего развития информатики, занимающейся изучением законов, методов и способов накопления, обработки и передачи информации с помощью компьютеров, ноутбуков и других технических средств. Методы и средства информатики реализуются в виде автоматизированных информационных технологий, называемых также новыми или современными.
Учебная дисциплина «Информационные системы и технологии» формирует знания и умения в области информационных технологий, необходимые для трудовой деятельности специалистов.
Данный курс преследует цель научить слушателей использовать современные информационные технологии, приобрести и закрепить навыки и методы работы с компьютером. Курс «Информационные системы и технологии» также учитывает современные тенденции развития информационного общества. Когда говорят о новых информационных технологиях, то чаще всего подразумевают все средства, основанные на последних достижениях цифровой и вычислительно техники. К ним относятся средства связи и телекоммуникаций, технические средства информатизации, а также самые мощные из устройств обработки информации – компьютеры.
Дисциплина «Информационные системы и технологии» ставит перед собой следующие цели:
- формировать и развивать у слушателей теоретические знания и практические навыки оптимальной организации информационных процессов, информационных систем;
- научить использовать новейшие компьютерные информационные технологии поиска, обработки и систематизации информации;
- познакомить слушателей с информационными системами, активно использующимися сегодня в трудовой деятельности;
- сформировать знания и практические навыки, необходимые для работы.
В результате освоения учебной дисциплины «Информационные системы и технологии» обучающийся должен знать:
- состав, функции и возможности использования информационных и телекоммуникационных технологий в профессиональной деятельности;
- основные правила и методы работы с пакетами прикладных программ.
В результате освоения учебной дисциплины обучающийся должен уметь использовать пакеты прикладных программ для формирования различного вида документации.

Программа разработана разработана на основе следующих нормативно-правовых актов и нормативно-технических документов:
· Федеральный закон от 29 декабря 2012 г. N 273-ФЗ "Об образовании в Российской Федерации".
· Федеральный закон от 10 января 2002 г. N 7-ФЗ "Об охране окружающей среды".
· Федеральный закон от 24 июня 1998 г. N 89-ФЗ "Об отходах производства и потребления".
· Постановление Правительства Российской Федерации от 16.05.2005 г. № 303 «О разграничении полномочий Федеральных органов исполнительной власти в области обеспечения биологической и химической безопасности Российской Федерации».
· Основы государственной политики в области обеспечения химической, биологической безопасности Российской Федерации на период до 2010 г. и дальнейшую перспективу, утвержденные Президентом Российской Федерации 04.12.2003 г. № Пр-2194.
· Приказ от 20 ноября 2007 г. №793 «О подготовке и аттестации руководителей и специалистов организаций в области обеспечения экологической безопасности».
Программа реализуется в соответствии с Требованиями к минимуму содержания дополнительной профессиональной образовательной программы повышения квалификации «Профессиональная подготовка лиц на право работы с отходами 1-4 класса опасности»
Программа разработана в целях осуществления единой государственной политики в области повышения квалификации руководящих работников и специалистов субъектов хозяйственной или иной деятельности, которая оказывает или может оказать негативное воздействие на окружающую среду с целью обновления их теоретических и практических знаний в связи с повышением требований к уровню квалификации и необходимостью освоения современных методов решения профессиональных задач в области обеспечения экологической безопасности при обращении с опасными отходами.

Дополнительная профессиональная программа повышения квалификации «Бактериологические исследования в лабораторной диагностике» (далее – Программа, ДПП ПК) предназначена для повышения квалификации специалистов с высшим медицинским образованием по основной специальности Бактериология;
по дополнительным специальностям: Вирусология, Генетика, Клиническая лабораторная диагностика, Лабораторная генетика, Медицинская биохимия, Медицинская микробиология, Паразитология.
Актуальность программы. Лабораторные исследования являются необходимым и первейшим мероприятием в постановке точного диагноза и последующем назначении адекватного и правильного лечения. По данным ВОЗ, при помощи лабораторных анализов специалист получает примерно до 80% точной информации о состоянии здоровья пациента. Особенно важное значение имеют профилактическая диагностика. При помощи анализов, проведённых в лаборатории, можно обнаружить начальные стадии болезни, когда самих симптомов ещё нет. Профилактические лабораторные исследования — это залог ранней своевременной диагностики и адекватной терапии. Лабораторные исследования занимают особое место в диагностике хронических заболеваний и инфекций.
В процессе изучения программы, обучающиеся познакомятся с актуальными вопросами по данному направлению.


Задача курса - совершенствование
профессиональной компетенции и повышение профессионального уровня в рамках
имеющейся квалификации специалистов со средним медицинским образованием по основной
специальности «Сестринское дело в педиатрии», а также актуализация и систематизация
полученных теоретических и практических знаний.



Актуальность программы обусловлена тем, что среди заболеваний, с которыми сталкивается врач, немалый удельный вес составляют болезни почек. Почки поражаются и при ряде других заболеваний, прежде всего системных, когда своевременное выявление и правильное понимание сущности обнаруживаемой нефропатии имеет важное практическое значение. Не редкость – возникновение нефропатии при различных лекарственных реакциях, особенно в связи с распространенной полипрагмазией.
Многие болезни почек встречаются у лиц молодого и среднего возраста, поэтому диагностика, лечение и профилактика болезней почек становится не только медицинской, но и социальной проблемой.
В процессе изучения программы, обучающиеся познакомятся с актуальными вопросами по данному направлению.

Актуальность дополнительной профессиональной программы повышения квалификации «Сестринское дело в ультразвуковой диагностике» обусловлена тем, что вопросы обеспечения высокого качества ультразвуковой диагностики, рационального использования ультразвуковой аппаратуры являются весьма актуальными для практического здравоохранения России. Недостаточная информированность специалистов о новейших методиках ультразвуковой диагностики, слабый внутриведомственный контроль, значительно снижает эффективность и своевременность постановки диагноза и проведение лечебных манипуляций.
В связи с этим повышение компетенций среднего медицинского персонала в вопросах проведения ультразвуковых исследований и интерпретировании полученных результатов особенно востребована и актуальна. В процессе изучения программы, обучающиеся познакомятся с актуальными вопросами по данному направлению.

Медицинские сестры - ключевые помощники врачей, и совершенствование их работы имеет решающее значение. Наша программа направлена на повышение качества сестринской деятельности, предоставляя сестрам новые навыки и знания.
Почему выбрать нашу программу?
Повышение профессионализма: Узнайте о планировании работы, организации обеспечения лекарственными средствами, документоведении и многом другом.
Модульная структура: Программа включает образовательные модули, разбитые на темы и элементы для удобного освоения.
Удобный формат: Обучение занимает всего 36 академических часов и проводится с использованием дистанционных технологий и электронного обучения.
Преимущества для вас:
Подготовьтесь к аттестации с нашим тестированием.
Поднимите уровень своей квалификации.
Обеспечьте качественное медицинское обслуживание для пациентов.

Медицинский массаж – это один из эффективных методов лечения различных заболеваний. Детский массаж, как правило, впервые назначается маленьким пациентам до года, начиная от двух-трех месяцев. Хотя опыт работы специалистов показывает, что массаж одинаково полезен в возрасте и двух, и трех лет, и старше.
Массаж и гимнастика, в комплексе с медикаментозной терапией, с первых дней жизни ребенка помогут предотвратить и устранить такие заболевания, как детские церебральные параличи, сколиозы и нарушения осанки, задержки речевого и психического развития, минимальные церебральные дисфункции и другие нарушения нервной системы и опорно-двигательного аппарата. Известно, что многие заболевания взрослых людей являются поздними проявлениями патологии в раннем детстве. В связи с этим крайне важно помочь избежать этого. Представленная программа будет способствовать выполнению этой задачи.
Требования к поступающему для обучения на программу слушателю:
наличие среднего профессионального (медицинского) образования по специальностям: «Медицинский массаж», «Лечебное дело», «Общая практика», «Реабилитационное сестринское дело», «Сестринское дело», «Сестринское дело в педиатрии».
Дополнительное профессиональное образование – программы профессиональной переподготовки по специальности «Медицинский массаж» при наличии среднего профессионального образования по одной из специальностей: «Лечебное дело», «Акушерское дело», «Сестринское дело».
Дополнительная профессиональная программа профессиональной переподготовки «Бактериология» предназначена для специалистов со средним профессиональным медицинским образованием с целью приобретения новых профессиональных компетенций по специальности «Бактериология».
Категория обучающихся: специалисты со средним профессиональным образованием по специальностям: «Лабораторная диагностика», «Медико-профилактическое дело».
Общая бактериология изучает морфологию, физиологию, биохимию бактерий, их изменчивость и наследственность, эволюцию, распространение в природе и др. Медицинская и ветеринарная бактериология изучают биологию болезнетворных бактерий, методы их выделения и определения, явления иммунитета, разрабатывают специфические средства предупреждения и лечения инфекционных болезней человека и животных.
Бактериологические методы лабораторной диагностики занимают ведущее место в клинико-диагностических показателях больного. Поэтому изучение его проведения, знание этапов, требований и деталей бактериологического анализа необходимо каждому специалисту медицинских специальностей.
Бактериологическое исследование − исследование, предназначенное для выделения бактерий и изучения их свойств с целью постановки микробиологического диагноза.
Основные разделы медицинской микробиологии – это медицинская бактериология (изучение этиологии заболеваний, вызываемых бактериями), медицинская вирусология (изучение этиологии заболеваний, вызываемых вирусами), медицинская микология (изучение этиологии заболеваний, вызываемых грибами).
Особенности реализации дополнительной профессиональной программы профессиональной переподготовки заключаются в реализации программы с применением дистанционных образовательных технологий и электронного обучения.
После успешного завершения обучения выдается диплом о профессиональной переподготовке.
Дополнительная профессиональная программа профессиональной переподготовки реализуется в заочной форме, рассчитана на 504 академических часа.
Форма итогового контроля - тестирование

Вы хотите стать профессионалом в области лабораторной диагностики? Тогда курс "Вы хотите стать профессионалом в области лабораторной диагностики? Тогда курс "Гистологические исследования в лабораторной диагностике" - это то, что вам нужно!
В рамках курса вы познакомитесь с основными методами гистологических исследований, научитесь правильно подготавливать препараты и интерпретировать результаты. Вы узнаете о тканевой микроскопии, методах окраски тканей, а также о технологиях обработки биологических материалов.
Курс проводят опытные специалисты, которые помогут вам разобраться в сложных вопросах и подскажут, как избежать ошибок при проведении исследований.
Знания, полученные в ходе курса, помогут вам стать более квалифицированным специалистом в области лабораторной диагностики и повысят вашу конкурентоспособность на рынке труда.
Не упустите возможность стать экспертом в гистологических исследованиях! Запишитесь на курс прямо сейчас!" - это то, что вам нужно!

Актуальность
Современная медицина располагает широкими диагностическими возможностями. Кроме опроса и осмотра пациента используются дополнительные методы исследования. Спектр исследований, проводимых пациентам для постановки диагноза, постоянно расширяется. Некоторые методы исследования применяются всем без исключения пациентам, другие проводятся по индивидуальным показаниям, в зависимости от пути диагностического поиска. Быстрота и достоверность результатов исследований напрямую зависит от того, насколько качественно проведена подготовка пациента к ним. Одним из видов такого исследования является холтеровское мониторирование. Сопровождение пациентов с холтеровским мониторированием требует от медицинских работников постоянного обновления знаний.
Требования к поступающему для обучения на программу слушателю:
Наличие среднего медицинского образования по специальности «Сестринское дело».

Хотите научиться эффективно и быстро реагировать на неотложные состояния у детей? Тогда наш курс обучения идеально подходит для вас!
В рамках курса вы познакомитесь с основными принципами и техниками проведения манипуляций при неотложных состояниях. Модуль 1 включает в себя изучение гипертермического синдрома, судорожного синдрома и носовых кровотечений.
В модуле 2 вы узнаете о основных респираторных синдромах, острой сердечной недостаточности, острых аллергических реакциях и коматозных состояниях при сахарном диабете.
Модуль 3 посвящен инфекционно-токсическому шоку, кишечному токсикозу с эксикозом и острым отравлениям.
Обучение проводится в дистанционном формате удобной, а после успешного окончания курса вы получите удостоверение и 36 ак.ч.

Данный учебный курс предоставляет информацию о важных аспектах введения лекарственных препаратов детям и процедуре взятия крови для лабораторных исследований в педиатрической практике. Курс охватывает особенности дозирования и выбора препаратов для детей, а также методы и техники безопасного и эффективного введения лекарств и процедуры взятия крови.

Дополнительная профессиональная программа повышения квалификации «Оказание экстренной медицинской и первой помощи» предназначена для повышения квалификации специалистов со средним медицинским образованием и разработана на основе ст. 31 Федерального закона от 21 ноября 2011 г. № 323-ФЗ «Об основах охраны здоровья граждан в Российской Федерации».
Дополнительная программа повышения квалификации реализуется в заочной форме, рассчитана на 36 академических часов. Форма итогового контроля- тестирование.

Программа учебного курса «Сестринское дело в косметологии» аккредитована на портале непрерывного медицинского и фармацевтического образования (НМФО) в объеме 144 академических часа, с присвоением соответствующего количества баллов
Аннотация
Актуальность представленной программы повышения квалификации «Сестринское дело в косметологии» обусловлена тем, что в настоящее время косметология является одной из самых динамично развивающихся направлений медицины.
Специалист со средним профессиональным образованием востребован в реалиях сегодняшнего дня ничуть не меньше, чем врач, специализирующийся в области косметологии. Спектр косметологических услуг, которые в силу своей компетенции может предоставить клиенту медицинская сестра по косметологии, чрезвычайно разнообразен.
Порядок оказания медицинской помощи по профилю косметология утвержден Приказом Министерства здравоохранения и социального развития Российской Федерации от 18 апреля 2012 года №381н. В нем дано определение медицинской помощи по профилю косметология:
Медицинская помощь по профилю косметология – это комплекс медицинских, психологических, гигиенических, реабилитационных мероприятий, направленных на сохранение или восстановление функциональной целостности покровных тканей человеческого организма (кожи, подкожной жировой клетчатки и поверхностных мышц).
Развитие и оказание медицинской помощи по профилю косметология включает:
• коррекцию врождённых и приобретённых морфофункциональных нарушений в составе покровных тканей человеческого организма с применением многокомпонентных факторов воздействия на ткани (лекарственные, физиотерапевтические, хирургические, биотканевые и другие разрешенные к медицинскому применению технологии);
• медицинский камуфляж (маскировка) косметических недостатков, не поддающихся коррекции, для улучшения социальной адаптации и психологической реабилитации пациентов;
• осуществление реабилитационных мероприятий после хирургического, химиотерапевтического, лучевого, медикаментозного воздействия;
• информирование населения в части гигиенических рекомендаций по предупреждению заболеваний, профилактике преждевременного старения и инволюционной деградации покровных тканей человеческого организма.
Медицинская помощь по профилю косметология может оказываться в медицинских организациях государственной системы здравоохранения (кожно-венерологические диспансеры, центры специализированных видов медицинской помощи, клиники медицинских научно-исследовательских учреждений, санаторно-курортные учреждения) и иных медицинских организациях независимо от их формы собственности и ведомственной принадлежности.
Основным требованием к медицинской сестре по косметологии является оказание квалифицированной косметологической помощи и косметических услуг пациентам на основе теоретических знаний, практических навыков и профессионального мастерства.

Работа среднего медицинского персонала включает в себя контакт с кровью и другими телесными жидкостями пациентов. В связи с этим, есть риск заражения ВИЧ-инфекцией при неправильном выполнении процедур, использовании нестерильного инструментария или при случайном проникновении крови инфицированного пациента на поврежденную кожу или слизистые оболочки здорового работника..
ВИЧ-инфекция остается серьезной проблемой в медицинской среде. Медицинский персонал, особенно тот, кто работает с кровью и другими инфекционными материалами, подвергается риску заражения ВИЧ-инфекцией. Правильное обучение и тренировка по мерам инфекционного контроля и профилактике являются необходимыми для предотвращения передачи инфекции и защиты здоровья медицинского персонала. Курс, который предлагает такое обучение, поможет повысить осведомленность и компетентность медицинского персонала в этой области и способствовать безопасности работников здравоохранения.

Современная медицина располагает широкими диагностическими возможностями. Кроме опроса и осмотра пациента используются дополнительные методы исследования. Спектр исследований, проводимых пациентам для постановки диагноза, постоянно расширяется. Одним из видов такого исследования является функциональная диагностика.
Функциона́льная диагно́стика — это обобщённое название функциональных методов исследования, которые широко применяются с целью раннего выявления патологии, дифференциальной диагностики различных заболеваний и контроля эффективности лечебно-оздоровительных мероприятий.
Медицинская сестра функциональной диагностики — это высококвалифицированный медицинский работник, который должен обладать навыками
проведения исследований с использованием современных методов и технологий. Быстрота и достоверность результатов исследований напрямую зависит от того, насколько качественно проведена подготовка пациента к ним.
Сопровождение пациентов при проведении обследования требует от медицинских работников постоянного обновления знаний. В процессе изучения программы, обучающиеся познакомятся с актуальными вопросами по данному направлению.
Содержание программы построено по модульному принципу. ДПП ПК содержит образовательные модули:
- Функциональные методы исследования;
- Функциональная диагностика в кардиологии;
- Функциональная диагностика в пульмонологии;
- Методы исследования в неврологии;
- Функциональная диагностика в гастроэнтерологии;
- Исследования в эндокринологии;
- Функциональная диагностика в нефрологии;
- Биоимпедансометрия.
Модули подразделяются на темы, каждая тема − на элементы. По окончании изучения курса предусмотрена аттестация в форме тестирования. Трудоемкость программы составляет 144 академических часов. Реализация обучения предполагается с использованием ДОТ и ЭО.

Актуальность программы обусловлена необходимостью освоения современных методов решения профессиональных задач, требующих от специалиста в области лабораторной диагностики со средним медицинским образованием обновленных профессиональных знаний.
Молекулярно-биологические методы анализа широко используются в медицинской практике, а также во многих других сферах. Непревзойденным молекулярно-биологическим методом является полимеразная цепная реакция (ПЦР) в разных вариантах её постановки. В настоящее время нельзя представить диагностику инфекционных заболеваний без использования метода ПЦР-диагностики. ПЦР фактически произвела революцию в диагностике инфекционных заболеваний, резко повысив эффективность расшифровки природы различных процессов, обусловленных бактериями, вирусами и микроскопическими грибами. Применение метода ПЦР помогает на самых ранних этапах заболевания выявить возбудителя, а также контролировать эффективность проводимой антимикробной терапии.
В процессе изучения программы, обучающиеся познакомятся с актуальными вопросами по данному направлению.
Содержание программы построено по модульному принципу. ДПП ПК содержит образовательные модули:
- Принцип метода ПЦР и механизм полимеразной цепной реакции;
- Этапы проведения ПЦР-исследования;
- Основные виды ошибок при проведении ПЦР-исследований;
- Контроль качества проведения ПЦР-исследований;
- ПЦР-исследования в клинической практике;
- ПЦР-исследования на современном этапе.
Модули подразделяются на темы, каждая тема − на элементы. По окончании изучения курса предусмотрена аттестация в форме тестирования. Трудоемкость программы составляет 72 академических часа. Реализация обучения предполагается с использованием ДОТ и ЭО.

Дополнительная профессиональная программа повышения квалификации «Организация работы медицинских сестер процедурных и прививочных кабинетов» предназначена для повышения квалификации специалистов со средним медицинским образованием и разработана на основе профессионального стандарта 02.065 «Сестринское дело» (утвержден приказом Министерства труда и социальной защиты Российской Федерации от 31 июля 2020 года № 475н).

Дополнительная профессиональная программа повышения квалификации «Актуальные вопросы вакцинации» является нормативно-методическим документом, регламентирующим содержание и организационно-методические формы обучения в дополнительном профессиональном образовании специалистов со средним медицинским образованием по основной специальности: Сестринское дело; по дополнительным специальностям: Акушерское дело, Лечебное дело, Общая практика, Организация сестринского дела, Сестринское дело в педиатрии.
Актуальность дополнительной профессиональной образовательной программы повышения квалификации «Актуальные вопросы вакцинации» обусловлена совершенствованием санитарно-эпидемиологического законодательства, необходимостью непрерывного обеспечения надлежащего уровня качества оказываемой населению первичной медико-санитарной помощи, в том числе в части иммунопрофилактики инфекционных заболеваний.
Медицинским сестрам необходимо знание актуальных вопросов вакцинопрофилактики в целях качественного и безопасного оказания медицинских услуг по проведению иммунопрофилактики инфекционных заболеваний в соответствии с национальным календарем профилактических прививок и по эпидемическим показаниям в медицинских организациях первичного звена.
В связи с этим потребность в подготовке медицинских работников по данной проблематике является особо значимой и актуальной в современных условиях развития здравоохранения.
Содержание программы построено в соответствии с модульным принципом.
Слушателям для изучения предлагаются следующие модули:
- общие вопросы вакцинопрофилактики;
- национальный календарь профилактических прививок и календарь прививок по эпидемиологическим показаниям;
- организация работы прививочного кабинета;
- технология вакцинации, противопоказания к вакцинации;
- патология поствакцинального периода;
- частные вопросы вакцинопрофилактики.
Каждый модуль подразделяется на темы, каждая тема − на элементы. По окончании изучения курса предусмотрена аттестация в форме тестирования. Трудоемкость программы составляет 36 академических часов. Реализация обучения предполагается с использованием ДОТ и ЭО.

Дополнительная профессиональная программа по циклу «Организация сестринского дела» предназначена для переподготовки специалистов со средним профессиональным образованием по специальности "Лечебное дело", "Акушерское дело" или "Сестринское дело", имеющих сертификат специалиста или свидетельство об аккредитации специалиста по специальности "Лечебное дело", "Акушерское дело" или "Сестринское дело", документ о повышении квалификации по специальности "Организация сестринского дела".
Программа составлена на основе Профессионального образовательного стандарта 2.069 «Специалист по организации сестринского дела». Утвержден приказом министерства труда и социальной защиты Российской Федерации от 31 июля 2020 года N 479н.
Изучение микроорганизмов всегда было актуальным направлением медицины, поэтому врачи в данной области весьма востребованы. А их работа с пациентами важна для сохранения жизни на земле. В данном курсе Вы познакомитесь с методом исследования - бактериология в медицине. Увидите в чем преимущество современной лабораторной диагностики в Компании Ситилаб.
В данном курсе 4 раздела из которых вы узнаете:
После курса можно проверить свои знания в тестировании, которое сформировано на информации полученной в данном курсе.
Успешного обучения!

Актуальность программы повышения квалификации дополнительного
профессионального образования «Профилактика акушерского травматизма» обусловлена необходимостью совершенствования
профессиональных знаний и получения новой компетенции в рамках имеющейся
квалификации врачей акушеров-гинекологов. Специалистам акушерско-гинекологической
службы необходимо углубление знаний по основным профессиональным проблемам с
учетом современных исследований, открытий, появлению новых технологий, новых
методов диагностики и лечения соответственно новым законодательным и нормативноправовым документам. Современное оказание квалифицированной помощи по профилю
«акушерство и гинекология» должно соответствовать приказу МЗ РФ №572 от 1 ноября
2012 года и Федеральному закону Российской Федерации от 21.11.2011 г. №323-ФЗ «Об
основах охраны здоровья граждан в Российской Федерации».
Настоящая программа дополнительного профессионального образования
«Профилактика акушерского травматизма» предназначена
для непрерывного профессионального образования врачей акушеров-гинекологов,
работающих в женских консультациях, акушерских и гинекологических стационарах и
рассчитана на 36 часов.

Данный курс относится к первому разделу Дополнительной профессиональной программы повышения квалификации «Первичная медико-профилактическая помощь населению (для медицинских сестер процедурного кабинета)» разработана АНО ДПО «НМЦО» на основе образовательной программы дополнительного профессионального образования по специальности «Сестринское дело».
Категория обучающихся: специалисты со средним профессиональным образованием по специальности «Сестринское дело»; специалисты со средним профессиональным образованием по специальности: «Лечебное дело», «Акушерское дело», прошедшие профессиональную переподготовку по специальности «Сестринское дело».

Дополнительная профессиональная программа повышения квалификации «Неотложные состояния в акушерстве» разработана в соответствии с Федеральным законом от 29 декабря 2012 г. №273-ФЗ «Об образовании в Российской Федерации», Приказом Министерства труда и социальной защиты РФ от 13.01. 2021 г. № 6н «Об утверждении профессионального стандарта «Акушерка (Акушер)».
Категория обучающихся: ДПП ПК предназначена для специалистов со средним профессиональным образованием по основной специальности «Акушерское дело», по дополнительной специальности: «Лечебное дело».
Трудоемкость обучения: 36 ч.
Срок обучения: 5 дней
Режим обучения: по индивидуальному графику.
Форма обучения: заочная, с использованием дистанционных образовательных технологий.
Форма итоговой аттестации: итоговое тестирование.
Выдаваемый документ: удостоверение о повышении квалификации.

Концепция развития здравоохранения и медицинской науки предусматривает переход к системе организации и оказания медицинской помощи по принципу единого лечащего врача, ответственного за состояние здоровья и профилактику заболеваний, допуск к профессии и иным видам деятельности, связанным с воздействием вредных факторов либо повышенной опасностью для пациента и окружающих.
С 1 апреля 2021 вступил в силу новый порядок проведения обязательных предварительных и периодических медицинских осмотров работников, утвержденный приказом Министерства здравоохранения РФ от 28.01.2021 №29н проведения медицинских осмотров.
Проводить медосмотр по новым правилам – это не только правильное оформление документов. Медицинские осмотры нацелены на выявление заболеваний на ранней стадии, предупреждение профзаболеваний. Право на осуществление экспертизы связи заболеваний с профессией предоставляется государственным (муниципальным) центрам профпатологии (Минздрава России на базе НИИ медицины труда РАМН, территориальным в субъектах РФ и ведомственным) и научно-исследовательским институтам системы Минздрава России, РАМН, имеющим в своей структуре клиники профпатологии, при наличии лицензии на данный вид деятельности.
В процессе изучения программы, обучающиеся познакомятся с актуальными вопросами по данному направлению.
Цель обучения: совершенствование профессиональной компетенции и повышение профессионального уровня в рамках имеющейся квалификации специалистов со средним профессиональным образованием по специальности "Сестринское дело", "Акушерское дело", Анестезиология и реаниматология", "Бактериология", "Лабораторная диагностика", "Лабораторное дело", "Лечебное дело", "Организация сестринского дела", "Реабилитационное сестринское дело", "Скора\ и неотложная помощь", "Эпидемиология".
Целевая аудитория программы: медицинская сестра, акушер, медицинский техник, медицинский технолог, фельдшер-лаборант

Медицинские осмотры работников, занятых на тяжелых работах и на работах с вредными и опасными условиями труда — один из важнейших компонентов профилактики профессиональных заболеваний и производственного травматизма. В марте 2022 года законодательство по медосмотрам претерпело изменения, поэтому в курсе представлена информация, как организовать медосмотры по-новому: приводим подробный алгоритм действий, пишем о нюансах работы с медорганизацией, необходимых документах, ответственности за отсутствие медосмотров и многом другом.

Дополнительная профессиональная программа по циклу
«Безопасность работы с паровыми стерилизаторами»
предназначена для повышения квалификации медицинских работников, имеющих среднее профессиональное образование по специальности «Лабораторная диагностика», «Бактериология», «Гистология», «Лабораторное дело».Программа составлена на основе Федерального образовательного стандарта среднего профессионального образования по специальности 31.02.03 "Лабораторная диагностика" (утв. приказом Министерства образования и науки РФ от 11 августа 2014 г. N 970).

Дополнительная профессиональная программа по циклу «Первичная медико-санитарная помощь детям» предназначена для повышения квалификации специалистов со средним профессиональным образованием по специальности "Лечебное дело", "Акушерское дело" или "Сестринское дело", имеющих сертификат специалиста или свидетельство об аккредитации специалиста по специальности "Лечебное дело", "Акушерское дело" или "Сестринское дело".
Программа составлена на основе Профессионального образовательного стандарта 34.02.01 «Сестринское дело» (утвержден приказом Минобрнауки Российской Федерации от 12.05.2014 N 502).

Дополнительная профессиональная программа повышения квалификации "Актуальные вопросы лабораторной диагностики ВИЧ-инфекции" предназначена для повышения квалификации специалистов со средним медицинским образованием и разработана на основе профессионального стандарта 02.071 «Специалист в области лабораторной диагностики со средним медицинским образованием».
1. Цель реализации программы заключается в совершенствовании профессиональных навыков сотрудников со средним медицинским образованием, занимающихся лабораторной диагностикой ВИЧ-инфекций.
Основные задачи программы:
- совершенствование компетенций, необходимых для проведения лабораторные исследований биологического материала на ВИЧ-инфекцию (первой и второй категории сложности) ;
- обеспечение качества лабораторных исследований ВИЧ-инфекции на аналитическом этапе.

Дополнительная профессиональная программа по циклу «Современные методы клинических исследований в лабораторной диагностике» предназначена для повышения квалификации специалистов со средним медицинским образованием по специальности «Лабораторная диагностика».

Дополнительная профессиональная программа по циклу «Автоклавирование в лабораториях и медицинских учреждениях»
Программа составлена на основе Федерального образовательного стандарта среднего профессионального образования по специальности 31.02.03 "Лабораторная диагностика" (утв. приказом Министерства образования и науки РФ от 11 августа 2014 г. N 970).

Актуальность программы. Согласно государственному докладу «О состоянии санитарно-эпидемиологического благополучия населения в Российской Федерации в 2019 году» эпидемиологическая ситуация в мире продолжает оставаться нестабильной. Благодаря предпринятым Роспотребнадзором дополнительным мерам по санитарной охране территории в 2019 году достигнуто снижение заболеваемости населения Российской Федерации по 11 паразитарным болезням.
Для стабилизации санитарно-эпидемиологической обстановки в стране необходимо непрерывно усовершенствовать профессиональные навыки и знания специалистов, занимающихся лабораторной диагностикой паразитарных заболеваний.
Дополнительная профессиональная программа повышения квалификации «Методы лабораторной диагностики паразитарных заболеваний» предназначена для повышения квалификации специалистов со средним медицинским образованием и разработана на основе профессионального стандарта 02.071 «Специалист в области лабораторной диагностики со средним медицинским образованием» (утвержден приказом Министерства труда и социальной защиты Российской Федерации от 31 июля 2020 года № 473н).

Дополнительная профессиональная программа повышения квалификации «Оказание экстренной медицинской и первой помощи» предназначена для повышения квалификации специалистов со средним медицинским образованием и разработана на основе профессионального стандарта 02.071 «Специалист в области лабораторной диагностики со средним медицинским образованием» (утвержден приказом Министерства труда и социальной защиты Российской Федерации от 31 июля 2020 года № 473н).
Дополнительная программа повышения квалификации реализуется в заочной форме, рассчитана на 18 академических часов. Форма итогового контроля- тестирование.

Дополнительная профессиональная программа по циклу «Обеспечение микробиологических работ в бактериологической лаборатории» предназначена для повышения квалификации специалистов со средним медицинским образованием образование по одной из специальностей: «Лабораторная диагностика», «Медико-профилактическое дело».
Программа составлена с учётом требований Федерального государственного образовательного стандарта среднего профессионального образования по специальности 31.02.03 Лабораторная диагностика (утвержден Приказом Минобрнауки России от 11 августа 2014 г. № 970), а также требований профессионального стандарта «Микробиолог» в части обобщенной трудовой функции А (утвержден приказом Министерства труда и социальной защиты РФ от 31.10.2014 г. № 865).
Трудоёмкость программы-36 часов.

Основным условием обеспечения безопасности гемотрансфузий является проведение полноценной иммуногематологической диагностики крови доноров и реципиентов компонентов крови. Для обеспечения медицинской помощи населению на всей территории страны все клинико-лабораторные иммуногематологические исследования должны осуществляться по единым стандартам в соответствии с утвержденной нормативной и инструктивной документацией. Дополнительная профессиональная программа повышения квалификации "Современные методы определения группы крови и резус-фактора" предназначена для повышения квалификации специалистов в области клинической лабораторной диагностики.
Дополнительная профессиональная программа повышения квалификации разработана на основе профессионального образовательного стандарта 02.032 «Специалист в области клинической лабораторной диагностики» (Приказ Министерства труда и социальной защиты Российской Федерации от 14 марта 2018 года № 145н) и реализуется в заочной форме.

Дополнительная профессиональная программа по циклу "Акушерское дело" объемом 144 ак. часа предназначена для повышения квалификации специалистов со средним медицинским образованием по специальности «Акушерское дело».
Цель реализации программы - совершенствование компетенций, необходимых для профессиональной деятельности; повышение профессионального уровня в рамках имеющейся квалификации.
Результатом освоения программы является овладение обучающимися следующими навыками:

Дополнительная профессиональная программа по циклу «Основы ЭКГ для среднего медицинского персонала» объемом 36 ак. часа является нормативно-методическим документом, регламентирующим содержание и организационно-методические формы обучения по профилю «Кардиология» в дополнительном профессиональном образовании специалистов с средним медицинским образованием.
Цель реализации программы заключается в совершенствовании профессиональных навыков специалистов с средним медицинским образованием, необходимым для регистрации и оценки результатов электрокардиографии.
Основные задачи программы:
- совершенствование знаний и компетенций об оказании медицинской помощи пациентам при заболеваниях и (или) состояниях сердечно-сосудистой системы;
- совершенствование знаний и компетенций при проведении обследования пациентов при заболеваниях и (или) состояниях сердечно-сосудистой системы с целью постановки диагноза;
- совершенствование знаний и компетенций по вопросам обеспечения требований безопасности при оказании медицинской помощи.

Дополнительная профессиональная программа по циклу "Алгоритм регистрации и основы расшифровки ЭКГ" объемом 18 ак. часа является нормативно-методическим документом, регламентирующим содержание и организационно-методические формы обучения по профилю «Кардиология»
Цель реализации программы заключается в совершенствовании профессиональных навыков специалистов со средним медицинским образованием, необходимым для регистрации и оценки результатов электрокардиографии.
Основные задачи программы:
- совершенствование знаний и компетенций об оказании медицинской помощи пациентам при заболеваниях и (или) состояниях сердечно-сосудистой системы;
- совершенствование знаний и компетенций при проведении обследования пациентов при заболеваниях и (или) состояниях сердечно-сосудистой системы с целью постановки диагноза;
- совершенствование знаний и компетенций по вопросам обеспечения требований безопасности при оказании медицинской помощи.

Дополнительная профессиональная программа повышения квалификации «Биологическая безопасность при работе с микроорганизмами различных групп патогенности» предназначена для повышения квалификации специалистов со средним медицинским образованием.
Актуальность и практическая значимость дополнительной профессиональной программы связана с необходимостью постоянного совершенствования профессиональных компетенций специалистов в области лабораторной диагностики в связи с угрозами, исходящими от инфекционных болезней и их возбудителей, приобретающими в современном мире глобальный характер.
Особенности реализации дополнительной профессиональной программы повышения квалификации заключаются в реализации программы с применением дистанционных образовательных технологий и электронного обучения. Для проведения семинарских занятий используется формат асинхронной веб-конференции.
После успешного завершения обучения по программе повышения квалификации выдается удостоверение о повышении квалификации.
Дополнительная профессиональная программа реализуется в заочной форме, рассчитана на 72 академических часов.
Форма итогового контроля - тестирование.


Дополнительная профессиональная программа повышения квалификации «Деятельность по обращению с медицинскими отходами» предназначена для повышения квалификации специалистов со средним медицинским образованием.
Актуальность и практическая значимость дополнительной профессиональной программы связана с необходимостью постоянного совершенствования профессиональных компетенций специалистов в связи с изменением нормативно-правового регулирования сферы обращения с медицинскими отходами, необходимостью непрерывного обеспечения надлежащего уровня качества оказываемой населению медицинской помощи, в том числе в части безопасности предоставляемых медицинских услуг, как одного из основных компонентов качества медицинской помощи.
Особенности реализации дополнительной профессиональной программы повышения квалификации заключаются в реализации программы с применением дистанционных образовательных технологий и электронного обучения. Для проведения семинарских занятий используется формат асинхронной веб-конференции.
После успешного завершения обучения по программе повышения квалификации выдается удостоверение о повышении квалификации.
Дополнительная профессиональная программа реализуется в заочной форме, рассчитана на 72 академических часов.
Форма итогового контроля - тестирование.

Актуальность дополнительной профессиональной образовательной программы повышения квалификации медицинских сестер по теме: «Оказание сестринской медицинской помощи» обусловлена изменением законодательства в отношении деятельности медицинской сестры(брата) и утверждением нового профстандарта, в котором особое внимание отведено сестринскому уходу и профилактики. Дополнительная профессиональная программа повышения квалификации «Стандарты сестринского дела» предназначена для повышения квалификации специалистов со средним медицинским образованием и разработана на основе профессионального стандарта 02.065 «Медицинская сестра/брат» (утвержден приказом Министерства труда и социальной защиты Российской Федерации от 31 июля 2020 года № 475н.

Актуальность программы повышения квалификации «Сестринское дело в стоматологии» обусловлена тем, что профессиональные навыки стоматологической сестры, знание сестринского процесса при стоматологических заболеваниях позволяет повысить качество оказываемой помощи.
Дополнительная профессиональная программа повышения квалификации «Сестринское дело в стоматологии» разработана в соответствии с профессиональным стандартом 02.065 Медицинская сестра/ медицинский брат (Приказ Министерства труда и социальной защиты Российской Федерации от 31 июля 2020 марта № 475 н).

Актуальность дополнительной программы повышения квалификации «Оборот наркотических средств и психотропных веществ в медицинских организациях» обусловлена изменениями в законодательстве по обороту наркотических средств и психотропных веществ. С 01 марта 2022 вступили в силу новые федеральные нормативные акты, регулирующие вопросы порядок назначения, отпуска, хранения, уничтожения, предметно-количественного учёта наркотических средств и психотропных веществ. Дополнительная профессиональная программа повышения квалификации «Оборот наркотических средств и психотропных веществ в медицинских организациях» предназначена для повышения квалификации специалистов со средним профессиональным образованием и разработана на основе профессионального стандарта 02.069 «Cпециалист по организации сестринского дела».
Дополнительная профессиональная программа повышения квалификации «Оборот наркотических средств и психотропных веществ в медицинских организациях» - совокупность документов, определяющих организацию образовательного процесса, в том числе цели, планируемые результаты повышения квалификации, учебный план, календарный учебный график, рабочие программы дисциплин (тем), организационно-педагогические условия, формы аттестации, оценочные материалы.

Дополнительная профессиональная программа повышения квалификации «Инфекционная безопасность в гемодиализе» предназначена для повышения квалификации специалистов со средним медицинским образованием и разработана на основе профессионального стандарта 02.065 «Медицинская сестра/Медицинский брат» (утверждён приказом Министерства труда и социальной защиты Российской Федерации от 31 июля 2020 года № 475 н).
Дополнительная профессиональная программа повышения квалификации реализуется в заочной форме.
Продолжительность обучения-36 ак. часов

Дополнительная профессиональная программа повышения квалификации «Стандарты сестринского дела» предназначена для повышения квалификации специалистов со средним медицинским образованием и разработана на основе профессионального стандарта 02.065 «Сестринское дело» (утвержден приказом Министерства труда и социальной защиты Российской Федерации от 31 июля 2020 года № 475н)., "Сестринское дело в педиатрии"

Дополнительная профессиональная программа по циклу «Организация сестринского дела» предназначена для повышения квалификации специалистов со средним профессиональным образованием по специальности "Лечебное дело", "Акушерское дело" или "Сестринское дело", имеющих сертификат специалиста или свидетельство об аккредитации специалиста по специальности "Лечебное дело", "Акушерское дело" или "Сестринское дело", документ о повышении квалификации по специальности "Организация сестринского дела".
Программа составлена на основе Профессионального образовательного стандарта 2.069 «Специалист по организации сестринского дела». Утвержден приказом министерства труда и социальной защиты Российской Федерации от 31 июля 2020 года N 479н.

Дополнительная профессиональная программа «Сестринское дело. Гемодиализ» предназначена для повышения квалификации специалистов среднего звена по специальности "Лечебное дело", "Акушерское дело" и "Сестринское дело"

Дополнительная профессиональная программа по циклу «Сестринское дело в гинекологии» предназначена для повышения квалификации медицинских работников, имеющих среднее профессиональное образование по специальности "Сестринское дело", "Лечебное дело" или "Акушерское дело".
Программа составлена на основе Профессионального Стандарта 02.065 «Медицинская сестра/ медицинский брат».


Цель курса - совершенствование профессиональной компетенции и повышение профессионального уровня в рамках имеющейся квалификации специалистов со средним медицинским образованием по основной специальности «Сестринское дело», а также актуализация и систематизация полученных теоретических и практических знаний.


Дополнительная профессиональная программа «Сестринское дело в педиатрии» предназначена для повышения квалификации специалистов со средним профессиональным образованием по специальности: «Сестринское дело»; специалисты со средним профессиональным образованием по специальности: «Лечебное дело», «Акушерское дело», прошедшие профессиональную переподготовку по специальности «Сестринское дело»

Что такое аллергия;
Что такое иммуноглобулин Е;
Какие существуют типы аллергических реакций;
Что такое иммуноглобулин и для чего он нужен;
Чем отличается пищевая аллерргия и пищевая непереносимость;
Какие тесты у нас есть.

Все мы в своей жизни рано ли поздно сталкиваемся с таким видом лекарств, как антибиотики. Часто их прием является жизненно необходимым для человека, просто для того, чтобы элементарно выжить.
Люди относятся к этому виду лекарств совершенно по-разному. Одни при любой, даже небольшой простуде, когда можно просто отлежаться и вообще ничего лекарственного не принимать, сразу бесконтрольно начинают их пить. Другие, даже подхватив сильную инфекцию, категорически отказываются от них и пытаются лечиться только народными средствами. Не надо впадать в крайности, а стараться придерживаться золотой середины и принимать лекарства по мере их необходимости.
На фоне таких поступков людей эффективность лечения резко снизилась. Именно поэтому сегодня Ситилаб имеет возможность найти врачу возможность подобрать именно эффективный препарат и сохранить пациенту здоровье.

Цель тренинга:
- формирование и развитие у участников тренинга навыков дополнительных продаж в медицинских центрах.
Категория обучающихся: администраторы медицинских центров; медицинские регистраторы; сотрудники, которые общаются с клиентами, обратившимися в МЦ для получения медицинских услуг.
Задачи тренинга:
1. Изучение специфики и методов допродаж в практике медицинских услуг.
2. Формирование и развитие навыков грамотной и эффективной работы сотрудников с клиентами Компании.
3. Формирование и развитие коммуникативных навыков сотрудников на этапе допродаж.
4. Повышение уровня продаж и прибыли Компании.

Широко распространенное в мире инфекционное заболевание, вызываемое микобактериями M. tuberculosis и другими близкородственными видами. По данным ВОЗ, только в 2016 году туберкулезом заболели более 10 млн человек, из них около 1 млн – дети в возрасте до 14 лет. При этом до четверти населения мира (преимущественно жители развивающихся стран) являются носителями латентной формы туберкулеза.
В случае снижения защитных факторов организма латентная форма заболевания может перейти в активную форму с последующим выделением бактерий и заражением остальных людей. Вероятность развития активной формы заболевания у носителя латентной инфекции составляет около 10%. Заболевание может длительно протекать бессимптомно, что существенно затрудняет диагностику туберкулеза.
Тест на содержание гамма-интерферона в образцах цельной крови для определения иммунного ответа на пептидные антигены ESAT-6, CFP-10 и TB7.7(p4) и называется Квантифероновым.
Конфликт — это нормальная часть здоровых отношений. В конце концов, два человека не могут быть всегда и во всем согласны. Умение действовать в конфликтных ситуациях, а не избегать их, является ключевым.
Освоив навыки решения конфликтов, Вы сможете сделать свои личные и профессиональные взаимоотношения сильными и развивающимися.

Постоянное наблюдение за пациентами необходимо для того, чтобы своевременно заметить изменения в состоянии их здоровья, обеспечить надлежащий уход и при необходимости оказать неотложную медицинскую помощь.

1. Статистические показатели здоровья населения.
2. Как подготовиться к исследованиям урогенитальной зоны.
3. Микрофлора мужчины и женщины. В чем особенности?
4. Что такое КВМ и ОБМ? Зачем они нужны в диагностике?
5. Краткие характеристики фемофлора и адрофлора. Актуальность их применения в медицине.


Медики исследовали положение дел в семейных парах и уровень рождаемости. Статистические данные показывают, что порядка 50% семей отмечают невозможность иметь столько детей, сколько они желают, по причине плохого здоровья мужчины или женщины. 16% семей остаются бездетными. Анализ информации, полученной при исследовании, позволил составить социологический прогноз с подробным научным обоснованием.


Для чего проводится тестирование?
В целях поддержания единых стандартов качества обслуживания пациентов, мы подводим итоги Глобального обучения среднего медицинского персонала СИТИЛАБ на портале дистанционного обучения (СДО). Данное тестирование позволит нам выявить зоны развития в качестве обслуживания пациентов, преаналитике, сформировать план обучения для сотрудников.
Условия: